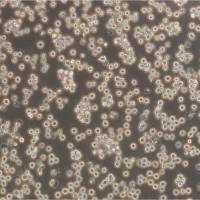
KHYG-1 Cells人自然杀伤细胞淋巴细胞白血病细胞传代培养|STR图谱

相关产品推荐更多 >
万千商家帮你免费找货
0 人在求购买到急需产品
- 详细信息
- 文献和实验
- 技术资料
- 品系:
详见细胞说明资料
- 细胞类型:
详见细胞说明资料
- 肿瘤类型:
详见细胞说明资料
- 供应商:
上海冠导生物工程有限公司
- 库存:
≥100瓶
- 生长状态:
详见细胞说明资料
- 年限:
详见细胞说明资料
- 运输方式:
常温运输【复苏细胞】或干冰运输【冻存细胞】
- 器官来源:
详见细胞说明资料
- 是否是肿瘤细胞:
详见细胞说明资料
- 细胞形态:
详见细胞说明资料
- 免疫类型:
详见细胞说明资料
- 物种来源:
详见细胞说明资料
- 相关疾病:
详见细胞说明资料
- 组织来源:
详见细胞说明资料
- 英文名:
H9/HTLV-IIIB人T淋巴瘤白血病细胞系
- 规格:
1*10(6)Cellls/瓶
"H9/HTLV-IIIB人T淋巴瘤白血病细胞系
传代比例:1:2-1:4(首次传代建议1:2)
生长特性:悬浮生长
换液周期:每周2-3次
冻存和复苏的原则:慢冻快融》当细胞冷到零度以下,可以产生以下变化:细胞器脱水,细胞中可溶性物质浓度升GAO,并在细胞内形成冰晶。如果缓慢冷冻,可使细胞逐步脱水,细胞内不致产生大的冰晶;相反,结晶就大,大结晶会造成细胞膜、纲胞器的损伤和破裂。复苏过程应快融,目的是防止小冰晶形成大冰晶,即冰晶的重结晶。慢冻程序》1.标准程序:采用细胞冻存器》当温度在-25℃以上时,1~2℃/min;当温度达-25℃以下时,5~10℃/min;当温度达-100℃时,可迅速放入中。2.简易程序:将冷冻管(管口要朝上)放入纱布袋内,纱布袋系以线绳,通过线绳将纱布袋固定于罐罐口,按每分钟温度下降1~2℃的速度,在40min内降至表面过夜,次晨投人中。3.传统程序:冷冻管置于4℃10分钟→-20℃30分钟→-80℃16~18小时(或隔夜)→槽长期储存。细胞冻存方法:1.预先配制冻存》(1)8%DMSO+细胞生长(92%血清)2.取对数生长期细胞,经胰酶消化后,加入适量冻存,用吸管吹打制成细胞悬(1×10(6)~5×10(6)细胞/ml)。3.加入1ml细胞于冻存管中,密封后标记冷冻细胞名称和冷冻日期。长期保存。保存细胞的复苏方法:1.快速解冻》冻存细胞从中取出后,立即放入37℃水浴中,轻轻摇动冷冻管,使其在1分钟内全部融化(不要超过3分钟)。2.解冻后的细胞可直接接种到含完全生长培养的细胞培养瓶中直接进行培养,24小时后再用新鲜完全培养替换旧培养,以去除DMSO。3.如果细胞对冷冻保护剂别敏感解冻后的细胞应先通过离心去除冷冻保护剂,然后再接种到含完全生长培养的培养瓶中。
H9/HTLV-IIIB人T淋巴瘤白血病细胞系
背景信息:详见相关文献介绍
┈订┈购┈热┈线:1┈5┈8┈0┈0┈5┈7┈6┈8┈6┈7【微信同号】┈Q┈Q:3┈3┈0┈7┈2┈0┈4┈2┈7┈1;
MV522 Cells;背景说明:肺腺癌;女性;传代方法:1:2-1:3传代;每周换液2-3次。;生长特性:贴壁;形态特性:详见产品说明;相关产品有:PANC-28 Cells、MCF-10A Cells、JROECL 33 Cells
SNU484 Cells;背景说明:详见相关文献介绍;传代方法:1:2传代;生长特性:贴壁或悬浮,详见产品说明部分;形态特性:详见产品说明;相关产品有:Hs819T Cells、NCIH64 Cells、OV-2008 Cells
MKN45 Cells;背景说明:该细胞系由S Akiyama建立,源于一位35岁患有印戒细胞癌的女性的胃淋巴结。;传代方法:1:2-1:3传代;每周换液2-3次。;生长特性:贴壁+悬浮;形态特性:淋巴母细胞;相关产品有:TE-671 Cells、MCMEC Cells、SVG(P12) Cells
NCI-H711 Cells;背景说明:详见相关文献介绍;传代方法:1:2-1:3传代;每周换液2-3次。;生长特性:贴壁或悬浮,详见产品说明部分;形态特性:详见产品说明;相关产品有:P3/X63/Ag8 Cells、BEL-7405 Cells、EoL-1-cell Cells
产品包装:复苏发货:T25培养瓶(一瓶)或冻存发货:1ml冻存管(两支)
来源说明:细胞主要来源ATCC、ECACC、DSMZ、RIKEN等细胞库
H9/HTLV-IIIB人T淋巴瘤白血病细胞系
细胞培养实验相关问题总结:支原体(mycoplasma)污染的细胞,是否能以肉眼观察出异状?不能。除有经验之专家外,大多数遭受支原体污染的细胞株,无法以其外观分辨之;支原体污染会对细胞培养有何影响?支原体污染几乎可影响所有细胞之生长参数,代谢及研究之任一数据。故进行实验前,必须确认细胞为mycoplasma-free,实验结果之数据方有意义;侦测出细胞株有支原体污染时,该如何处理?直接灭菌后丢弃,以避免污染其它细胞株;CO2培养箱之水盘如何保持清洁?定期(至少每两周一次) 以无菌蒸馏水或无菌去离子水更换之;为何培养基保存于4°C冰箱中,颜色会偏暗红色,且pH值会越来越偏碱性?培养基保存于4°C冰箱中,培养基内之CO2会逐渐溢出,造成培养基越来越偏碱性。而培养基中之碱指示剂(通常为phenol red)的颜色也会随碱性增加而更偏暗红。培养基偏碱之结果,将造成细胞生长停滞或死亡。若培养基偏碱时,可以通入无菌过滤之CO2,以调整pH值;购买之细胞冷冻管经解冻后,为何会发生细胞数目太少之情形?研究人员在冷冻细胞之培养时出现细胞数目太少,大都是因为离心过程操作上的失误,造成细胞的物理性损伤,以及细胞流失。建议细胞解冻后不要立刻离心,应待细胞生长隔夜后再更换培养基即可;购买之细胞死亡或细胞存活率不佳可能原因?研究人员在细胞培养时出现存活率不佳,常见原因可归纳为:培养基使用错误或培养基品质不佳。血清使用错误或血清的品质不佳。解冻过程错误。冷冻细胞解冻后,加以洗涤细胞和离心。悬浮细胞误认为死细胞。培养温度使用错误。细胞置于–80°C太久;收到之冷冻管瓶身破裂,瓶盖有裂纹,或瓶盖脱落之原因?冷冻管瓶盖裂纹,或瓶身破裂,可能是因为操作者夹取冷冻管时用力不当,造成冷冻管裂损,建议使用止血钳小心夹取。另冷冻管瓶盖松动或松脱,乃因热胀冷缩之物理现象,冷冻管有可能因此而造成细胞污染,故冷冻管于放入和取出桶时,均应立刻将冷冻管再一次扭紧。
RPE-1 Cells;背景说明:视网膜色素上皮;hTERT永生;女性;传代方法:1:2-1:3传代;每周换液2-3次。;生长特性:贴壁;形态特性:详见产品说明;相关产品有:Human Hepatocyte Line 5 Cells、H-1793 Cells、HFLS Cells
Turbot Embryonic Cell line Cells;背景说明:胸腺;上皮 Cells;传代方法:1:2-1:3传代;每周换液2-3次。;生长特性:贴壁;形态特性:详见产品说明;相关产品有:RAOEC Cells、SKNEP Cells、Caco-2/BBe Cells
PANC.1 Cells;背景说明:这株人胰腺癌细胞株源自于胰腺癌导管细胞,其倍增时间为52小时。染色体研究表明,该细胞染色体众数为63,包括3个独特标记的染色体和1个小环状染色体。该细胞的生长可被1unit/ml的左旋天冬酰胺酶抑制;能在软琼脂上生长;能在裸鼠上成瘤。;传代方法:1:2-1:4传代;每周2-3次。;生长特性:贴壁生长;形态特性:上皮样;多角形;相关产品有:HEK293T/17 Cells、Kupffer Cells、SCC 9 Cells
物种来源:人源、鼠源等其它物种来源
┈订┈购┈热┈线:1┈5┈8┈0┈0┈5┈7┈6┈8┈6┈7【微信同号】┈Q┈Q:3┈3┈0┈7┈2┈0┈4┈2┈7┈1;
形态特性:淋巴母细胞样
细胞传代培养的胰酶消化法:传代培养:是指细胞从一个培养瓶以1:2或1:2以上的比例转移,接种到另一培养瓶的培养。传代细胞,可根据不同细胞采取不同的方法进行细胞传代。贴壁生长的细胞用消化法传代,部分贴壁的细胞用直接吹打或用硅胶软刮的刮除法传代。悬浮细胞可采用加入等量新鲜培养基后直接吹打分散进行传代,或用自然沉降法加入新培养基后再吹打分散进行传代。实验步骤:①入无菌室之前用肥皂洗手,再用75% 的酒精擦拭消毒双手;②倒置显微镜下观察细胞形态,确定细胞是否传代及细胞需要稀释的倍数。将培养用37℃下预热;③超净台台面应整洁,用75%酒精棉球擦拭清洁;④打开超净工作台的紫外灯照射台面20min左右,关闭紫外灯,打开风机清洁空气除去臭氧;⑤点燃酒精灯;取出无菌试管,巴士德吸管和刻度吸管;安上橡皮头;过酒精灯火焰略烧后插在无菌试管内;⑥将培养用瓶口用75%酒精消毒,过酒精灯火焰后斜置于酒精灯旁的架子上;⑦倒掉培养细胞的旧培养基。酌情可用2-3ml Hanks洗去残留的就培养基,或用少量胰酶涮洗一下;⑧每个大培养瓶加入1ml胰酶,小培养瓶用量酌减,盖HAO瓶盖后在倒置显微镜下观察。当细胞收回突起变圆时立即翻转培养瓶,使细胞脱离胰酶,然后将胰酶倒掉。注意勿使细胞提早脱落入消化中;⑨加入少量的含血清的新鲜培养基,反复吹打消化HAO的细胞使其脱壁并分散,再根据分传瓶数补加一定量的含血清的新鲜培养基(7-10ml/大瓶;3-5ml/小瓶)制成细胞悬,然后分装到新培养瓶中。盖HAO瓶盖,适度拧紧后稍回转,以利于CO2的进入,将培养瓶放回CO2培养箱;⑩对悬浮培养细胞,步骤7-9不做。直接将细胞悬进行离心去除旧培养基上清,加入新鲜培养基,然后分装到各瓶中。
IPLB-Sf21 Cells;背景说明:详见相关文献介绍;传代方法:1:2-1:3传代;每周换液2-3次。;生长特性:贴壁或悬浮,详见产品说明部分;形态特性:详见产品说明;相关产品有:OV-2008 Cells、HNTEC Cells、KYSE-510 Cells
ARO81-1 Cells;背景说明:甲状腺癌;女性;传代方法:1:2-1:3传代;每周换液2-3次。;生长特性:贴壁;形态特性:详见产品说明;相关产品有:IBRS2 Cells、Bowes melanoma cells Cells、CoCL2 Cells
NCI-H1703 Cells;背景说明:该细胞1987年建系,源自一位54岁患有非小细胞肺癌的白人男性,该患者为吸烟者。;传代方法:1:3—1:6传代,每周换液2—3次;生长特性:贴壁生长;形态特性:上皮细胞样;相关产品有:LC1sq Cells、NH-6 Cells、OVCAR3 Cells
FL 62891 Cells;背景说明:肝;SV40转化;男性;传代方法:1:2-1:3传代;每周换液2-3次。;生长特性:贴壁;形态特性:详见产品说明;相关产品有:HL60 Cells、NCI-SNU-216 Cells、KPL-1 Cells
MV 3 Cells;背景说明:黑色素瘤;淋巴结转移;男性;传代方法:1:2-1:3传代;每周换液2-3次。;生长特性:贴壁;形态特性:详见产品说明;相关产品有:MDAMB361 Cells、UCLA SO M21 Cells、Stanford University Pediatric T-cell line 1 Cells
K562/ADR Cells;背景说明:详见相关文献介绍;传代方法:1:2-1:3传代;每周换液2-3次。;生长特性:贴壁或悬浮,详见产品说明部分;形态特性:详见产品说明;相关产品有:LCMS Cells、PG-4 Cells、HSC-I Cells
SK-NSH Cells;背景说明:SK-N-SH细胞系由J.L.Bieder建系,它与SK-N-MC所不同的是倍增时间较长且多巴胺-β-羟基酶水平较高。 SK-N-SH在细胞介导的细胞毒性试验中用作靶细胞系。;传代方法:1:2传代;生长特性:悬浮生长;形态特性:上皮细胞样;相关产品有:COV-362 Cells、HCC 38 Cells、C4-1 Cells
SKRC-52 Cells;背景说明:肾癌;纵隔膜转移;传代方法:1:2-1:3传代;每周换液2-3次。;生长特性:贴壁;形态特性:详见产品说明;相关产品有:VA-ES-BJ Cells、Ly19 Cells、Sci-1 Cells
MLTC-1 Cells;背景说明:睾丸间质瘤;传代方法:1:2-1:3传代;每周换液2-3次。;生长特性:贴壁;形态特性:详见产品说明;相关产品有:MV3 Cells、HemECs Cells、SK N SH Cells
HCa/16A3-F Cells;背景说明:肝癌;传代方法:1:2-1:3传代;每周换液2-3次。;生长特性:贴壁;形态特性:详见产品说明;相关产品有:SHEP1 Cells、CCK-81 Cells、RA.1 Cells
SF-539 BT Cells;背景说明:胶质瘤;女性;传代方法:1:2-1:3传代;每周换液2-3次。;生长特性:贴壁;形态特性:详见产品说明;相关产品有:SCL1 Cells、Liver-02 Cells、RMC Cells
GM0637 Cells;背景说明:详见相关文献介绍;传代方法:1:2-1:3传代;每周换液2-3次。;生长特性:贴壁或悬浮,详见产品说明部分;形态特性:详见产品说明;相关产品有:SUM149 Cells、TOV112D Cells、Leukemic 1210 Cells
RKO Cells;背景说明:RKO是一个低分化的结肠癌细胞系。RKO细胞含有野生型P53,但缺乏人甲状腺受体核受体(h-TRbeta1)。RKO细胞的P53蛋白的水平高于RKO-E6细胞。RKO细胞系是RKO-E6和RKO-AS45-1的亲本细胞系。该细胞系在裸鼠中成瘤,且在软琼脂中形成集落。;传代方法:消化3-5分钟。1:2。3天内可长满。;生长特性:贴壁生长;形态特性:上皮样;相关产品有:WM451Lu Cells、SKML-28 Cells、HSC(Human Schwann) Cells
SW-1573 Cells;背景说明:详见相关文献介绍;传代方法:1:2-1:3传代;每周换液2-3次。;生长特性:贴壁或悬浮,详见产品说明部分;形态特性:详见产品说明;相关产品有:MDBK (NBL-1) Cells、IM 9 Cells、NR 8383 Cells
NFS-60 Cells;背景说明:详见相关文献介绍;传代方法:1:3传代;生长特性:贴壁生长;形态特性:上皮细胞样;相关产品有:Hs-600-T Cells、MeSoTheliOma-211H Cells、293 H Cells
H9/HTLV-IIIB人T淋巴瘤白血病细胞系
HEMCSS Cells;背景说明:详见相关文献介绍;传代方法:1:4-1:8传代;每周换液3次。;生长特性:贴壁生长;形态特性:详见产品说明;相关产品有:STTG1 Cells、SKCO 1 Cells、RL95 Cells
LADMAC Cells;背景说明:骨髓淋巴细胞;C3H;传代方法:1:2-1:3传代;每周换液2-3次。;生长特性:悬浮;形态特性:详见产品说明;相关产品有:TO175T Cells、MRC 5 Cells、FHCRC subclone 11 Cells
Abcam HCT 116 FEN1 KO Cells(拥有STR基因鉴定图谱)
AG06292 Cells(拥有STR基因鉴定图谱)
BayGenomics ES cell line CSI617 Cells(拥有STR基因鉴定图谱)
BayGenomics ES cell line RST749 Cells(拥有STR基因鉴定图谱)
BIHi269-A Cells(拥有STR基因鉴定图谱)
CIBi005-A Cells(拥有STR基因鉴定图谱)
┈订┈购┈热┈线:1┈5┈8┈0┈0┈5┈7┈6┈8┈6┈7【微信同号】┈Q┈Q:3┈3┈0┈7┈2┈0┈4┈2┈7┈1;
DA03222 Cells(拥有STR基因鉴定图谱)
DT40-ORAI2(-/-) Cells(拥有STR基因鉴定图谱)
GM03983 Cells(拥有STR基因鉴定图谱)
SU-DHL-10 Cells;背景说明:详见相关文献介绍;传代方法:1:2-1:3传代;每周换液2-3次。;生长特性:悬浮;形态特性:淋巴母细胞;相关产品有:BC-020 Cells、Rat-2 Cells、NCIH2170 Cells
H2228 Cells;背景说明:详见相关文献介绍;传代方法:1:2-1:3传代,每周2-3次。;生长特性:贴壁生长;形态特性:详见产品说明;相关产品有:Ocular Choroidal Melanoma-1 Cells、N87 Cells、210RCY3-Ag1.2.3 Cells
KG-1 Cells;背景说明:详见相关文献介绍;传代方法:1:3传代,2-3天传一代;生长特性:悬浮生长;形态特性:原粒细胞;相关产品有:SPC-A1 Cells、Hs 895.T Cells、AMJ2-C8 Cells
G422 Cells;背景说明:1964年建株;甲基胆蒽植入Km小鼠脑内诱发星形细胞瘤,传至第120代后转为胶质细胞瘤;瘤细胞悬液同系小鼠皮下、肌肉、脑内移植,成功率皆100%。肌肉及脑内移植可形成较规律的移植性瘤株,存活时间脑内型15.9±4.8天;肌肉型20.3±6.6天。;传代方法:1:2传代;生长特性:体内生长;形态特性:实体瘤;相关产品有:SKGT2 Cells、B16F1 Cells、H-2170 Cells
Leghorn Male Hepatoma cell line Cells;背景说明:肝癌;雄性;传代方法:1:2-1:3传代;每周换液2-3次。;生长特性:贴壁;形态特性:详见产品说明;相关产品有:2V6.11 Cells、P-19 Cells、COR-L 105 Cells
MNNG/HOS Clone F-5 Cells;背景说明:骨肉瘤;女性;传代方法:1:2-1:3传代;每周换液2-3次。;生长特性:贴壁;形态特性:详见产品说明;相关产品有:SJSA1 Cells、DHL-16 Cells、GM02131A Cells
RT-BM Cells;背景说明:详见相关文献介绍;传代方法:1:2传代;生长特性:贴壁生长;形态特性:成神经细胞;相关产品有:DHL6 Cells、H-740 Cells、OKAC1 Cells
MNNG-HOS (Cl#5) Cells;背景说明:骨肉瘤;女性;传代方法:1:2-1:3传代;每周换液2-3次。;生长特性:贴壁;形态特性:详见产品说明;相关产品有:P31-FUJ Cells、HCGC Cells、Hi-5 Cells
MC-38 Cells;背景说明:详见相关文献介绍;传代方法:1:2传代;生长特性:贴壁生长;形态特性:上皮细胞样;相关产品有:OE-21 Cells、SUDHL8 Cells、HeLa S3 Cells
RL95-2 Cells;背景说明:这些细胞有α角蛋白,定义明确的连接复合体,张力丝和表面微绒毛。;传代方法:1:2传代;生长特性:贴壁生长;形态特性:上皮样;相关产品有:Clone 166 Cells、GM03570 Cells、Molm 13 Cells
4T1.2 Cells;背景说明:乳腺癌;雌性;BALB/cfC3H;传代方法:1:2-1:3传代;每周换液2-3次。;生长特性:贴壁;形态特性:详见产品说明;相关产品有:SHG-44 Cells、143 B Cells、Colon26 Cells
Tu 212 Cells;背景说明:详见相关文献介绍;传代方法:1:2传代;生长特性:贴壁生长 ;形态特性:详见产品说明;相关产品有:H-187 Cells、769P Cells、ssMCF7 Cells
NCTC-929 Cells;背景说明:详见相关文献介绍;传代方法:1:2-1:3传代;每周换液2-3次。;生长特性:贴壁或悬浮,详见产品说明部分;形态特性:详见产品说明;相关产品有:SW1417 Cells、HGSMC Cells、HO8910PM Cells
7-1 [Mouse hybridoma against ouabain] Cells(拥有STR基因鉴定图谱)
P31FUJ Cells;背景说明:详见相关文献介绍;传代方法:1:5传代;生长特性:悬浮生长;形态特性:淋巴母细胞;相关产品有:DHL-16 Cells、ME1 Cells、FU-OV-1 Cells
EOC20 Cells;背景说明:详见相关文献介绍;传代方法:1:2-1:3传代;每周换液2-3次。;生长特性:贴壁或悬浮,详见产品说明部分;形态特性:详见产品说明;相关产品有:COV-434 Cells、AgC11x3A Cells、Madin-Darby Canine Kidney Cells
CP-70 Cells;背景说明:卵巢癌;女性;传代方法:1:2-1:3传代;每周换液2-3次。;生长特性:贴壁;形态特性:详见产品说明;相关产品有:MHCC97-H Cells、SNU-5 Cells、UMC-11 Cells
G 292 Clone A 141B1 Cells;背景说明:详见相关文献介绍;传代方法:1:2-1:3传代;每周换液2-3次。;生长特性:贴壁或悬浮,详见产品说明部分;形态特性:详见产品说明;相关产品有:T-HEECs Cells、COV504 Cells、X63-AG 8.653 Cells
BERH-2 Cells;背景说明:肝癌;传代方法:1:2-1:3传代;每周换液2-3次。;生长特性:贴壁;形态特性:详见产品说明;相关产品有:MM1-S Cells、HL-7702 Cells、Roswell Park Memorial Institute 2650 Cells
THP1 Cells;背景说明:该细胞从一名1岁的患有急性单核细胞性白血病的男孩的外周血中分离建立。该细胞可以吞噬乳胶颗粒和激活的红细胞,细胞膜和胞浆内均没有免疫球蛋白,表达C3R和FcR;可受佛波酯TPA诱导向单核系方向分化;可作为转染宿主。;传代方法:维持细胞浓度在2-4×105-8×105/ml,勿超过1×106/ml;2-3天换液1次。;生长特性:悬浮生长;形态特性:单核细胞;相关产品有:HBVP Cells、WM115-mel Cells、MUTZ3 Cells
NCI.H522 Cells;背景说明:详见相关文献介绍;传代方法:1:3-1:6传代;每周换液2-3次。;生长特性:贴壁生长;形态特性:上皮样;相关产品有:PG-4 (S+L-) Cells、GM03573A Cells、NS1-1 Ag4.1 Cells
Tu-686 Cells;背景说明:详见相关文献介绍;传代方法:1:2传代;生长特性:贴壁生长 ;形态特性:详见产品说明;相关产品有:HEK-AD 293 Cells、Tohoku Hospital Pediatrics-1 Cells、ROS 17/2.8 Cells
GM10542 Cells(拥有STR基因鉴定图谱)
HAP1 CD2BP2 (-) 1 Cells(拥有STR基因鉴定图谱)
MALME 3M Cells;背景说明:详见相关文献介绍;传代方法:1:2-1:4传代,2天换液1次。;生长特性:混合生长;形态特性:成纤维细胞;相关产品有:A204 Cells、HaCaT Cells、MDCK II Cells
HG03857 Cells(拥有STR基因鉴定图谱)
IL-A24 Cells(拥有STR基因鉴定图谱)
LSV5 Cells(拥有STR基因鉴定图谱)
ND01091 Cells(拥有STR基因鉴定图谱)
PC6-12 Cells(拥有STR基因鉴定图谱)
Ubigene HeLa ATP13A2 KO Cells(拥有STR基因鉴定图谱)
WT-CLS1 Cells(拥有STR基因鉴定图谱)
HAP1 SOAT1 (-) 1 Cells(拥有STR基因鉴定图谱)
AU 565 Cells;背景说明:详见相关文献介绍;传代方法:1:4—1:6传代;每3-5天换一次液。;生长特性:贴壁生长;形态特性:上皮细胞;相关产品有:Det 562 Cells、OCM1 Cells、WC00097 Cells
MDA-415 Cells;背景说明:这株细胞表达WNT7B癌基因。8168088].带瘤患者来自巴拉圭,虽然填报的是白人,但细胞表型存在G6PDA型,显示其属于混血。细胞株形成平展延伸的上皮细胞样,在电镜下呈现结节,伴随着延伸的微管和微板。不容易用胰酶消化。;传代方法:消化5-10分钟。1:2。4-5天长满。;生长特性:贴壁生长;形态特性:上皮细胞;相关产品有:HUVEC Cells、Mouse INsulinoma 6 Cells、C22 (Clara) Cells
FAO-1 Cells;背景说明:详见相关文献介绍;传代方法:1:2-1:3传代;每周换液2-3次。;生长特性:贴壁或悬浮,详见产品说明部分;形态特性:上皮细胞;相关产品有:LS 174 T Cells、CORL23 Cells、NCI-H2330 Cells
MRCV Cells;背景说明:MRC-5细胞系来自14周龄男性胎儿的正常肺组织,该细胞老化前能传代42~46个倍增时间。;传代方法:1:2-1:5传代;每周1-2次。;生长特性:贴壁生长;形态特性:成纤维细胞样;相关产品有:NCI-H524 Cells、BEP2D Cells、D-283 Cells
FM-88 Cells;背景说明:详见相关文献介绍;传代方法:1:2-1:3传代;每周换液2-3次。;生长特性:贴壁或悬浮,详见产品说明部分;形态特性:详见产品说明;相关产品有:KM H-2 Cells、MC26 Cells、N1E115 Cells
FM-88 Cells;背景说明:详见相关文献介绍;传代方法:1:2-1:3传代;每周换液2-3次。;生长特性:贴壁或悬浮,详见产品说明部分;形态特性:详见产品说明;相关产品有:KM H-2 Cells、MC26 Cells、N1E115 Cells
ASPC1 Cells;背景说明:该细胞来源于人胰腺癌裸鼠异种移植产生的癌性腹水,可以表达CEA,人胰腺相关抗原、人胰腺特异性抗原和黏蛋白。;传代方法:1:3-1:6传代;每周换液2-3次。;生长特性:贴壁生长;形态特性:上皮样;相关产品有:HT-144 Cells、TE671/RD Cells、MFM223 Cells
LS180 Cells;背景说明:详见相关文献介绍;传代方法:1:2-1:3传代;每周换液2-3次。;生长特性:贴壁或悬浮,详见产品说明部分;形态特性:详见产品说明;相关产品有:SW982 Cells、MDA-MB453 Cells、Hs 294T Cells
MCF12A Cells;背景说明:非致瘤性乳腺上皮细胞;女性;传代方法:1:2-1:3传代;每周换液2-3次。;生长特性:贴壁;形态特性:详见产品说明;相关产品有:EST50 Cells、NCI-SNU-C2B Cells、GC-2 Cells
HS578 Cells;背景说明:详见相关文献介绍;传代方法:1:2-1:3传代;每周换液2-3次。;生长特性:贴壁或悬浮,详见产品说明部分;形态特性:详见产品说明;相关产品有:CAMA-1 Cells、SCCVII/St Cells、MT-3 [Human leukocytes] Cells
FL62891 Cells;背景说明:肝;SV40转化;男性;传代方法:1:2-1:3传代;每周换液2-3次。;生长特性:贴壁;形态特性:详见产品说明;相关产品有:PCI-SG231 Cells、SNU-601 Cells、SNU-668 Cells
FOX-NY Cells;背景说明:详见相关文献介绍;传代方法:1:2-1:3传代;每周换液2-3次。;生长特性:贴壁或悬浮,详见产品说明部分;形态特性:详见产品说明;相关产品有:A-875 Cells、C8161 Cells、MLO-Y4 Cells
Lewis lung carcinoma line 1 Cells;背景说明:详见相关文献介绍;传代方法:1:2-1:3传代;每周换液2-3次。;生长特性:贴壁或悬浮,详见产品说明部分;形态特性:详见产品说明;相关产品有:MDA157 Cells、IPEC-1 Cells、SNU119 Cells
MV4:11 Cells;背景说明:详见相关文献介绍;传代方法:1:2-1:3传代;每周换液2-3次。;生长特性:贴壁或悬浮,详见产品说明部分;形态特性:详见产品说明;相关产品有:P30OHK Cells、K1 Cells、BXPC3 Cells
NKL Cells;背景说明:NK细胞淋巴瘤/白血病;男性;传代方法:1:2-1:3传代;每周换液2-3次。;生长特性:悬浮;形态特性:详见产品说明;相关产品有:Kobe university Oral Squamous Cell culture-2 Cells、C4-2 B Cells、SW 1222 Cells
SCRP0307i Cells(拥有STR基因鉴定图谱)
COLO-699 Cells;背景说明:详见相关文献介绍;传代方法:1:2-1:3传代;每周换液2-3次。;生长特性:贴壁或悬浮,详见产品说明部分;形态特性:详见产品说明;相关产品有:LI7 Cells、CMT-64 Cells、BSC-1 Cells
U-373MG ATCC Cells;背景说明:胶质瘤;男性;传代方法:1:2-1:3传代;每周换液2-3次。;生长特性:贴壁;形态特性:详见产品说明;相关产品有:IPLB-Sf21-AE Cells、A2780-CP Cells、HK-2 [Human kidney] Cells
ST 486 Cells;背景说明:详见相关文献介绍;传代方法:每2-3天换液;生长特性:悬浮生长 ;形态特性:淋巴母细胞样;相关产品有:HCEC-B4G12 Cells、KLN 205 Cells、BMF Cells
MDA-MB-231-GFP Cells;背景说明:详见相关文献介绍;传代方法:1:2-1:3传代;每周换液2-3次。;生长特性:贴壁或悬浮,详见产品说明部分;形态特性:详见产品说明;相关产品有:EJ Cells、LuCL4 Cells、BTI-Tn-5B1-4 Cells
Jurkat FHCRC Cells;背景说明:该细胞源自一位14岁患有T淋巴细胞白血病男性的外周血;传代方法:保持细胞密度在3—9×105cells/ml之间,1:5—1:10传代,每周换液2—3次;生长特性:悬浮生长;形态特性:圆形,单个或呈片;相关产品有:SCC-1395 Cells、KMY1022 Cells、SNK6 Cells
GM05887A Cells;背景说明:详见相关文献介绍;传代方法:1:2—1:5传代;每周换液2-3次;生长特性:贴壁生长;形态特性:混合型;相关产品有:MDCK Type II Cells、H2196 Cells、CORL51 Cells
┈订┈购┈热┈线:1┈5┈8┈0┈0┈5┈7┈6┈8┈6┈7【微信同号】┈Q┈Q:3┈3┈0┈7┈2┈0┈4┈2┈7┈1;
ST2 Cells;背景说明:基质;BALB/c;传代方法:1:2-1:3传代;每周换液2-3次。;生长特性:贴壁;形态特性:详见产品说明;相关产品有:R D Cells、RS4:11 Cells、Hs675 Cells
H711 Cells;背景说明:详见相关文献介绍;传代方法:1:2-1:3传代;每周换液2-3次。;生长特性:贴壁或悬浮,详见产品说明部分;形态特性:详见产品说明;相关产品有:IMCD-3 Cells、SW 982 Cells、MGHU3 Cells
TSU-Pr1 Cells;背景说明:详见相关文献介绍;传代方法:1:2传代;生长特性:贴壁生长;形态特性:上皮细胞样;相关产品有:H1568 Cells、COLO-829 Cells、R.K.13 Cells
CII Cells;背景说明:慢性淋巴细胞白血病;女性;传代方法:1:2-1:3传代;每周换液2-3次。;生长特性:悬浮;形态特性:详见产品说明;相关产品有:MLFC Cells、H-735 Cells、LS411 Cells
A2780S Cells;背景说明:详见相关文献介绍;传代方法:1:2传代;生长特性:贴壁生长;形态特性:上皮细胞样;相关产品有:OE-33 Cells、FCCH1018 Cells、MAC1 Cells
RL Cells;背景说明:详见相关文献介绍;传代方法:每周换液2-3次。;生长特性:悬浮生长 ;形态特性:淋巴母细胞样;相关产品有:SCC90 Cells、HIBEpiC Cells、SW 1573 Cells
M059J Cells;背景说明:详见相关文献介绍;传代方法:1:6-1:8传代;每周换液2-3次。;生长特性:贴壁生长;形态特性:成纤维细胞;相关产品有:MGECs Cells、SKBR-3 Cells、MDCC MSB1 Cells
H9/HTLV-IIIB人T淋巴瘤白血病细胞系
SU-DHL-16 Cells;背景说明:详见相关文献介绍;传代方法:1:2-1:3传代;每周换液2-3次。;生长特性:贴壁或悬浮,详见产品说明部分;形态特性:详见产品说明;相关产品有:RPMI8226 Cells、C4 I Cells、OUMS27 Cells
BayGenomics ES cell line RRN132 Cells(拥有STR基因鉴定图谱)
BayGenomics ES cell line YHA186 Cells(拥有STR基因鉴定图谱)
H20E03 Cells(拥有STR基因鉴定图谱)
P4bis Cells(拥有STR基因鉴定图谱)
ACK30 Cells(拥有STR基因鉴定图谱)
HOC519 Cells(拥有STR基因鉴定图谱)
" "PubMed=19727395; DOI=10.1371/journal.pone.0006888; PMCID=PMC2731225
Wadlow R.C., Wittner B.S., Finley S.A., Bergquist H., Upadhyay R., Finn S.P., Loda M., Mahmood U., Ramaswamy S.
Systems-level modeling of cancer-fibroblast interaction.
PLoS ONE 4:E6888-E6888(2009)
PubMed=20164919; DOI=10.1038/nature08768; PMCID=PMC3145113
Bignell G.R., Greenman C.D., Davies H.R., Butler A.P., Edkins S., Andrews J.M., Buck G., Chen L., Beare D., Latimer C., Widaa S., Hinton J., Fahey C., Fu B.-Y., Swamy S., Dalgliesh G.L., Teh B.T., Deloukas P., Yang F.-T., Campbell P.J., Futreal P.A., Stratton M.R.
Signatures of mutation and selection in the cancer genome.
Nature 463:893-898(2010)
PubMed=20215515; DOI=10.1158/0008-5472.CAN-09-3458; PMCID=PMC2881662
Rothenberg S.M., Mohapatra G., Rivera M.N., Winokur D., Greninger P., Nitta M., Sadow P.M., Sooriyakumar G., Brannigan B.W., Ulman M.J., Perera R.M., Wang R., Tam A., Ma X.-J., Erlander M., Sgroi D.C., Rocco J.W., Lingen M.W., Cohen E.E.W., Louis D.N., Settleman J., Haber D.A.
A genome-wide screen for microdeletions reveals disruption of polarity complex genes in diverse human cancers.
Cancer Res. 70:2158-2164(2010)
PubMed=20557307; DOI=10.1111/j.1349-7006.2010.01622.x; PMCID=PMC11158680
Iwakawa R., Kohno T., Enari M., Kiyono T., Yokota J.
Prevalence of human papillomavirus 16/18/33 infection and p53 mutation in lung adenocarcinoma.
Cancer Sci. 101:1891-1896(2010)
PubMed=21498706
Onitsuka T., Uramoto H., Tanaka F.
Lack of direct association between EGFR mutations and ER beta expression in lung cancer.
Anticancer Res. 31:855-860(2011)
PubMed=22460905; DOI=10.1038/nature11003; PMCID=PMC3320027
Barretina J.G., Caponigro G., Stransky N., Venkatesan K., Margolin A.A., Kim S., Wilson C.J., Lehar J., Kryukov G.V., Sonkin D., Reddy A., Liu M., Murray L., Berger M.F., Monahan J.E., Morais P., Meltzer J., Korejwa A., Jane-Valbuena J., Mapa F.A., Thibault J., Bric-Furlong E., Raman P., Shipway A., Engels I.H., Cheng J., Yu G.-Y.K., Yu J.-J., Aspesi P. Jr., de Silva M., Jagtap K., Jones M.D., Wang L., Hatton C., Palescandolo E., Gupta S., Mahan S., Sougnez C., Onofrio R.C., Liefeld T., MacConaill L.E., Winckler W., Reich M., Li N.-X., Mesirov J.P., Gabriel S.B., Getz G., Ardlie K., Chan V., Myer V.E., Weber B.L., Porter J., Warmuth M., Finan P., Harris J.L., Meyerson M.L., Golub T.R., Morrissey M.P., Sellers W.R., Schlegel R., Garraway L.A.
The Cancer Cell Line Encyclopedia enables predictive modelling of anticancer drug sensitivity.
Nature 483:603-607(2012)
PubMed=22961666; DOI=10.1158/2159-8290.CD-12-0112; PMCID=PMC3567922
Byers L.A., Wang J., Nilsson M.B., Fujimoto J., Saintigny P., Yordy J.S., Giri U., Peyton M., Fan Y.-H., Diao L.-X., Masrorpour F., Shen L., Liu W.-B., Duchemann B., Tumula P., Bhardwaj V., Welsh J., Weber S., Glisson B.S., Kalhor N., Wistuba I.I., Girard L., Lippman S.M., Mills G.B., Coombes K.R., Weinstein J.N., Minna J.D., Heymach J.V.
Proteomic profiling identifies dysregulated pathways in small cell lung cancer and novel therapeutic targets including PARP1.
Cancer Discov. 2:798-811(2012)
PubMed=25008024; DOI=10.1007/s10735-014-9583-2
Wang J., Wei H., Zhao B.-X., Li M., Lv W.-P., Lv L., Song B., Lv S.
The reverse effect of X-ray irradiation on acquired gefitinib resistance in non-small cell lung cancer cell line NCI-H1975 in vitro.
J. Mol. Histol. 45:641-652(2014)
PubMed=25984343; DOI=10.1038/sdata.2014.35; PMCID=PMC4432652
Cowley G.S., Weir B.A., Vazquez F., Tamayo P., Scott J.A., Rusin S., East-Seletsky A., Ali L.D., Gerath W.F.J., Pantel S.E., Lizotte P.H., Jiang G.-Z., Hsiao J., Tsherniak A., Dwinell E., Aoyama S., Okamoto M., Harrington W., Gelfand E.T., Green T.M., Tomko M.J., Gopal S., Wong T.C., Li H.-B., Howell S., Stransky N., Liefeld T., Jang D., Bistline J., Meyers B.H., Armstrong S.A., Anderson K.C., Stegmaier K., Reich M., Pellman D., Boehm J.S., Mesirov J.P., Golub T.R., Root D.E., Hahn W.C.
Parallel genome-scale loss of function screens in 216 cancer cell lines for the identification of context-specific genetic dependencies.
Sci. Data 1:140035-140035(2014)
PubMed=25483995; DOI=10.3892/mmr.2014.3058
Zhao B.-X., Wang J., Song B., Wei H., Lv W.-P., Tian L.-M., Li M., Lv S.
Establishment and biological characteristics of acquired gefitinib resistance in cell line NCI-H1975/gefinitib-resistant with epidermal growth factor receptor T790M mutation.
Mol. Med. Rep. 11:2767-2774(2015)
PubMed=25485619; DOI=10.1038/nbt.3080
Klijn C., Durinck S., Stawiski E.W., Haverty P.M., Jiang Z.-S., Liu H.-B., Degenhardt J., Mayba O., Gnad F., Liu J.-F., Pau G., Reeder J., Cao Y., Mukhyala K., Selvaraj S.K., Yu M.-M., Zynda G.J., Brauer M.J., Wu T.D., Gentleman R.C., Manning G., Yauch R.L., Bourgon R., Stokoe D., Modrusan Z., Neve R.M., de Sauvage F.J., Settleman J., Seshagiri S., Zhang Z.-M.
A comprehensive transcriptional portrait of human cancer cell lines.
Nat. Biotechnol. 33:306-312(2015)
PubMed=25877200; DOI=10.1038/nature14397
Yu M., Selvaraj S.K., Liang-Chu M.M.Y., Aghajani S., Busse M., Yuan J., Lee G., Peale F.V., Klijn C., Bourgon R., Kaminker J.S., Neve R.M.
A resource for cell line authentication, annotation and quality control.
Nature 520:307-311(2015)
PubMed=26202522; DOI=10.1021/acs.jproteome.5b00477; PMCID=PMC4761227
Kitata R.B., Dimayacyac-Esleta B.R.T., Choong W.-K., Tsai C.-F., Lin T.-D., Tsou C.-C., Weng S.-H., Chen Y.-J., Yang P.-C., Arco S.D., Nesvizhskii A.I., Sung T.-Y., Chen Y.-J.
Mining missing membrane proteins by high-pH reverse-phase stagetip fractionation and multiple reaction monitoring mass spectrometry.
J. Proteome Res. 14:3658-3669(2015)
PubMed=26554430; DOI=10.1021/acs.analchem.5b03639
Dimayacyac-Esleta B.R.T., Tsai C.-F., Kitata R.B., Lin P.-Y., Choong W.-K., Lin T.-D., Wang Y.-T., Weng S.-H., Yang P.-C., Arco S.D., Sung T.-Y., Chen Y.-J.
Rapid high-pH reverse phase stagetip for sensitive small-scale membrane proteomic profiling.
Anal. Chem. 87:12016-12023(2015)
PubMed=26589293; DOI=10.1186/s13073-015-0240-5; PMCID=PMC4653878
Scholtalbers J., Boegel S., Bukur T., Byl M., Goerges S., Sorn P., Loewer M., Sahin U., Castle J.C.
TCLP: an online cancer cell line catalogue integrating HLA type, predicted neo-epitopes, virus and gene expression.
Genome Med. 7:118.1-118.7(2015)
PubMed=27397505; DOI=10.1016/j.cell.2016.06.017; PMCID=PMC4967469
Iorio F., Knijnenburg T.A., Vis D.J., Bignell G.R., Menden M.P., Schubert M., Aben N., Goncalves E., Barthorpe S., Lightfoot H., Cokelaer T., Greninger P., van Dyk E., Chang H., de Silva H., Heyn H., Deng X.-M., Egan R.K., Liu Q.-S., Miroo T., Mitropoulos X., Richardson L., Wang J.-H., Zhang T.-H., Moran S., Sayols S., Soleimani M., Tamborero D., Lopez-Bigas N., Ross-Macdonald P., Esteller M., Gray N.S., Haber D.A., Stratton M.R., Benes C.H., Wessels L.F.A., Saez-Rodriguez J., McDermott U., Garnett M.J.
A landscape of pharmacogenomic interactions in cancer.
Cell 166:740-754(2016)
PubMed=27835594; DOI=10.18632/oncotarget.13150; PMCID=PMC5348415
Tang Z.-H., Jiang X.-M., Guo X., Fong C.M.V., Chen X.-P., Lu J.-J.
Characterization of osimertinib (AZD9291)-resistant non-small cell lung cancer NCI-H1975/OSIR cell line.
Oncotarget 7:81598-81610(2016)
PubMed=28196595; DOI=10.1016/j.ccell.2017.01.005; PMCID=PMC5501076
Li J., Zhao W., Akbani R., Liu W.-B., Ju Z.-L., Ling S.-Y., Vellano C.P., Roebuck P., Yu Q.-H., Eterovic A.K., Byers L.A., Davies M.A., Deng W.-L., Gopal Y.N.V., Chen G., von Euw E.M., Slamon D.J., Conklin D., Heymach J.V., Gazdar A.F., Minna J.D., Myers J.N., Lu Y.-L., Mills G.B., Liang H.
Characterization of human cancer cell lines by reverse-phase protein arrays.
Cancer Cell 31:225-239(2017)
PubMed=29444439; DOI=10.1016/j.celrep.2018.01.051; PMCID=PMC6343826
Yuan T.L., Amzallag A., Bagni R., Yi M., Afghani S., Burgan W., Fer N., Strathern L.A., Powell K., Smith B., Waters A.M., Drubin D.A., Thomson T., Liao R., Greninger P., Stein G.T., Murchie E., Cortez E., Egan R.K., Procter L., Bess M., Cheng K.T., Lee C.-S., Lee L.C., Fellmann C., Stephens R., Luo J., Lowe S.W., Benes C.H., McCormick F.
Differential effector engagement by oncogenic KRAS.
Cell Rep. 22:1889-1902(2018)
PubMed=29681454; DOI=10.1016/j.cell.2018.03.028; PMCID=PMC5935540
McMillan E.A., Ryu M.-J., Diep C.H., Mendiratta S., Clemenceau J.R., Vaden R.M., Kim J.-H., Motoyaji T., Covington K.R., Peyton M., Huffman K., Wu X.-F., Girard L., Sung Y., Chen P.-H., Mallipeddi P.L., Lee J.Y., Hanson J., Voruganti S., Yu Y., Park S., Sudderth J., DeSevo C., Muzny D.M., Doddapaneni H., Gazdar A.F., Gibbs R.A., Hwang T.H., Heymach J.V., Wistuba I.I., Coombes K.R., Williams N.S., Wheeler D.A., MacMillan J.B., DeBerardinis R.J., Roth M.G., Posner B.A., Minna J.D., Kim H.S., White M.A.
Chemistry-first approach for nomination of personalized treatment in lung cancer.
Cell 173:864-878.e29(2018)
PubMed=30710758; DOI=10.1016/j.jprot.2019.01.018
Bottger F., Schaaij-Visser T.B.M., de Reus I., Piersma S.R., Pham T.V., Nagel R., Brakenhoff R.H., Thunnissen E., Smit E.F., Jimenez C.R.
Proteome analysis of non-small cell lung cancer cell line secretomes and patient sputum reveals biofluid biomarker candidates for cisplatin response prediction.
J. Proteomics 196:106-119(2019)
PubMed=30894373; DOI=10.1158/0008-5472.CAN-18-2747; PMCID=PMC6445675
Dutil J., Chen Z.-H., Monteiro A.N.A., Teer J.K., Eschrich S.A.
An interactive resource to probe genetic diversity and estimated ancestry in cancer cell lines.
Cancer Res. 79:1263-1273(2019)
PubMed=30971826; DOI=10.1038/s41586-019-1103-9
Behan F.M., Iorio F., Picco G., Goncalves E., Beaver C.M., Migliardi G., Santos R., Rao Y., Sassi F., Pinnelli M., Ansari R., Harper S., Jackson D.A., McRae R., Pooley R., Wilkinson P., van der Meer D.J., Dow D., Buser-Doepner C.A., Bertotti A., Trusolino L., Stronach E.A., Saez-Rodriguez J., Yusa K., Garnett M.J.
Prioritization of cancer therapeutic targets using CRISPR-Cas9 screens.
Nature 568:511-516(2019)
PubMed=31068700; DOI=10.1038/s41586-019-1186-3; PMCID=PMC6697103
Ghandi M., Huang F.W., Jane-Valbuena J., Kryukov G.V., Lo C.C., McDonald E.R. 3rd, Barretina J.G., Gelfand E.T., Bielski C.M., Li H.-X., Hu K., Andreev-Drakhlin A.Y., Kim J., Hess J.M., Haas B.J., Aguet F., Weir B.A., Rothberg M.V., Paolella B.R., Lawrence M.S., Akbani R., Lu Y.-L., Tiv H.L., Gokhale P.C., de Weck A., Mansour A.A., Oh C., Shih J., Hadi K., Rosen Y., Bistline J., Venkatesan K., Reddy A., Sonkin D., Liu M., Lehar J., Korn J.M., Porter D.A., Jones M.D., Golji J., Caponigro G., Taylor J.E., Dunning C.M., Creech A.L., Warren A.C., McFarland J.M., Zamanighomi M., Kauffmann A., Stransky N., Imielinski M., Maruvka Y.E., Cherniack A.D., Tsherniak A., Vazquez F., Jaffe J.D., Lane A.A., Weinstock D.M., Johannessen C.M., Morrissey M.P., Stegmeier F., Schlegel R., Hahn W.C., Getz G., Mills G.B., Boehm J.S., Golub T.R., Garraway L.A., Sellers W.R.
Next-generation characterization of the Cancer Cell Line Encyclopedia.
Nature 569:503-508(2019)
PubMed=31803961; DOI=10.1002/jcb.29564; PMCID=PMC7496084
Mulshine J.L., Ujhazy P., Antman M., Burgess C.M., Kuzmin I.A., Bunn P.A. Jr., Johnson B.E., Roth J.A., Pass H.I., Ross S.M., Aldige C.R., Wistuba I.I., Minna J.D.
From clinical specimens to human cancer preclinical models -- a journey the NCI-cell line database-25 years later.
J. Cell. Biochem. 121:3986-3999(2020)
PubMed=31978347; DOI=10.1016/j.cell.2019.12.023; PMCID=PMC7339254
Nusinow D.P., Szpyt J., Ghandi M., Rose C.M., McDonald E.R. 3rd, Kalocsay M., Jane-Valbuena J., Gelfand E.T., Schweppe D.K., Jedrychowski M.P., Golji J., Porter D.A., Rejtar T., Wang Y.K., Kryukov G.V., Stegmeier F., Erickson B.K., Garraway L.A., Sellers W.R., Gygi S.P.
Quantitative proteomics of the Cancer Cell Line Encyclopedia.
Cell 180:387-402.e16(2020)
PubMed=32351780; DOI=10.7717/peerj.8779; PMCID=PMC7183755
Wu J.-Y., Hao Z.-F., Ma C., Li P.-F., Dang L.-Y., Sun S.-S.
Comparative proteogenomics profiling of non-small and small lung carcinoma cell lines using mass spectrometry.
PeerJ 8:e8779.1-e8779.19(2020)"
传代比例:1:2-1:4(首次传代建议1:2)
生长特性:悬浮生长
换液周期:每周2-3次
冻存和复苏的原则:慢冻快融》当细胞冷到零度以下,可以产生以下变化:细胞器脱水,细胞中可溶性物质浓度升GAO,并在细胞内形成冰晶。如果缓慢冷冻,可使细胞逐步脱水,细胞内不致产生大的冰晶;相反,结晶就大,大结晶会造成细胞膜、纲胞器的损伤和破裂。复苏过程应快融,目的是防止小冰晶形成大冰晶,即冰晶的重结晶。慢冻程序》1.标准程序:采用细胞冻存器》当温度在-25℃以上时,1~2℃/min;当温度达-25℃以下时,5~10℃/min;当温度达-100℃时,可迅速放入中。2.简易程序:将冷冻管(管口要朝上)放入纱布袋内,纱布袋系以线绳,通过线绳将纱布袋固定于罐罐口,按每分钟温度下降1~2℃的速度,在40min内降至表面过夜,次晨投人中。3.传统程序:冷冻管置于4℃10分钟→-20℃30分钟→-80℃16~18小时(或隔夜)→槽长期储存。细胞冻存方法:1.预先配制冻存》(1)8%DMSO+细胞生长(92%血清)2.取对数生长期细胞,经胰酶消化后,加入适量冻存,用吸管吹打制成细胞悬(1×10(6)~5×10(6)细胞/ml)。3.加入1ml细胞于冻存管中,密封后标记冷冻细胞名称和冷冻日期。长期保存。保存细胞的复苏方法:1.快速解冻》冻存细胞从中取出后,立即放入37℃水浴中,轻轻摇动冷冻管,使其在1分钟内全部融化(不要超过3分钟)。2.解冻后的细胞可直接接种到含完全生长培养的细胞培养瓶中直接进行培养,24小时后再用新鲜完全培养替换旧培养,以去除DMSO。3.如果细胞对冷冻保护剂别敏感解冻后的细胞应先通过离心去除冷冻保护剂,然后再接种到含完全生长培养的培养瓶中。
H9/HTLV-IIIB人T淋巴瘤白血病细胞系
背景信息:详见相关文献介绍
┈订┈购┈热┈线:1┈5┈8┈0┈0┈5┈7┈6┈8┈6┈7【微信同号】┈Q┈Q:3┈3┈0┈7┈2┈0┈4┈2┈7┈1;
MV522 Cells;背景说明:肺腺癌;女性;传代方法:1:2-1:3传代;每周换液2-3次。;生长特性:贴壁;形态特性:详见产品说明;相关产品有:PANC-28 Cells、MCF-10A Cells、JROECL 33 Cells
SNU484 Cells;背景说明:详见相关文献介绍;传代方法:1:2传代;生长特性:贴壁或悬浮,详见产品说明部分;形态特性:详见产品说明;相关产品有:Hs819T Cells、NCIH64 Cells、OV-2008 Cells
MKN45 Cells;背景说明:该细胞系由S Akiyama建立,源于一位35岁患有印戒细胞癌的女性的胃淋巴结。;传代方法:1:2-1:3传代;每周换液2-3次。;生长特性:贴壁+悬浮;形态特性:淋巴母细胞;相关产品有:TE-671 Cells、MCMEC Cells、SVG(P12) Cells
NCI-H711 Cells;背景说明:详见相关文献介绍;传代方法:1:2-1:3传代;每周换液2-3次。;生长特性:贴壁或悬浮,详见产品说明部分;形态特性:详见产品说明;相关产品有:P3/X63/Ag8 Cells、BEL-7405 Cells、EoL-1-cell Cells
产品包装:复苏发货:T25培养瓶(一瓶)或冻存发货:1ml冻存管(两支)
来源说明:细胞主要来源ATCC、ECACC、DSMZ、RIKEN等细胞库
H9/HTLV-IIIB人T淋巴瘤白血病细胞系
细胞培养实验相关问题总结:支原体(mycoplasma)污染的细胞,是否能以肉眼观察出异状?不能。除有经验之专家外,大多数遭受支原体污染的细胞株,无法以其外观分辨之;支原体污染会对细胞培养有何影响?支原体污染几乎可影响所有细胞之生长参数,代谢及研究之任一数据。故进行实验前,必须确认细胞为mycoplasma-free,实验结果之数据方有意义;侦测出细胞株有支原体污染时,该如何处理?直接灭菌后丢弃,以避免污染其它细胞株;CO2培养箱之水盘如何保持清洁?定期(至少每两周一次) 以无菌蒸馏水或无菌去离子水更换之;为何培养基保存于4°C冰箱中,颜色会偏暗红色,且pH值会越来越偏碱性?培养基保存于4°C冰箱中,培养基内之CO2会逐渐溢出,造成培养基越来越偏碱性。而培养基中之碱指示剂(通常为phenol red)的颜色也会随碱性增加而更偏暗红。培养基偏碱之结果,将造成细胞生长停滞或死亡。若培养基偏碱时,可以通入无菌过滤之CO2,以调整pH值;购买之细胞冷冻管经解冻后,为何会发生细胞数目太少之情形?研究人员在冷冻细胞之培养时出现细胞数目太少,大都是因为离心过程操作上的失误,造成细胞的物理性损伤,以及细胞流失。建议细胞解冻后不要立刻离心,应待细胞生长隔夜后再更换培养基即可;购买之细胞死亡或细胞存活率不佳可能原因?研究人员在细胞培养时出现存活率不佳,常见原因可归纳为:培养基使用错误或培养基品质不佳。血清使用错误或血清的品质不佳。解冻过程错误。冷冻细胞解冻后,加以洗涤细胞和离心。悬浮细胞误认为死细胞。培养温度使用错误。细胞置于–80°C太久;收到之冷冻管瓶身破裂,瓶盖有裂纹,或瓶盖脱落之原因?冷冻管瓶盖裂纹,或瓶身破裂,可能是因为操作者夹取冷冻管时用力不当,造成冷冻管裂损,建议使用止血钳小心夹取。另冷冻管瓶盖松动或松脱,乃因热胀冷缩之物理现象,冷冻管有可能因此而造成细胞污染,故冷冻管于放入和取出桶时,均应立刻将冷冻管再一次扭紧。
RPE-1 Cells;背景说明:视网膜色素上皮;hTERT永生;女性;传代方法:1:2-1:3传代;每周换液2-3次。;生长特性:贴壁;形态特性:详见产品说明;相关产品有:Human Hepatocyte Line 5 Cells、H-1793 Cells、HFLS Cells
Turbot Embryonic Cell line Cells;背景说明:胸腺;上皮 Cells;传代方法:1:2-1:3传代;每周换液2-3次。;生长特性:贴壁;形态特性:详见产品说明;相关产品有:RAOEC Cells、SKNEP Cells、Caco-2/BBe Cells
PANC.1 Cells;背景说明:这株人胰腺癌细胞株源自于胰腺癌导管细胞,其倍增时间为52小时。染色体研究表明,该细胞染色体众数为63,包括3个独特标记的染色体和1个小环状染色体。该细胞的生长可被1unit/ml的左旋天冬酰胺酶抑制;能在软琼脂上生长;能在裸鼠上成瘤。;传代方法:1:2-1:4传代;每周2-3次。;生长特性:贴壁生长;形态特性:上皮样;多角形;相关产品有:HEK293T/17 Cells、Kupffer Cells、SCC 9 Cells
物种来源:人源、鼠源等其它物种来源
┈订┈购┈热┈线:1┈5┈8┈0┈0┈5┈7┈6┈8┈6┈7【微信同号】┈Q┈Q:3┈3┈0┈7┈2┈0┈4┈2┈7┈1;
形态特性:淋巴母细胞样
细胞传代培养的胰酶消化法:传代培养:是指细胞从一个培养瓶以1:2或1:2以上的比例转移,接种到另一培养瓶的培养。传代细胞,可根据不同细胞采取不同的方法进行细胞传代。贴壁生长的细胞用消化法传代,部分贴壁的细胞用直接吹打或用硅胶软刮的刮除法传代。悬浮细胞可采用加入等量新鲜培养基后直接吹打分散进行传代,或用自然沉降法加入新培养基后再吹打分散进行传代。实验步骤:①入无菌室之前用肥皂洗手,再用75% 的酒精擦拭消毒双手;②倒置显微镜下观察细胞形态,确定细胞是否传代及细胞需要稀释的倍数。将培养用37℃下预热;③超净台台面应整洁,用75%酒精棉球擦拭清洁;④打开超净工作台的紫外灯照射台面20min左右,关闭紫外灯,打开风机清洁空气除去臭氧;⑤点燃酒精灯;取出无菌试管,巴士德吸管和刻度吸管;安上橡皮头;过酒精灯火焰略烧后插在无菌试管内;⑥将培养用瓶口用75%酒精消毒,过酒精灯火焰后斜置于酒精灯旁的架子上;⑦倒掉培养细胞的旧培养基。酌情可用2-3ml Hanks洗去残留的就培养基,或用少量胰酶涮洗一下;⑧每个大培养瓶加入1ml胰酶,小培养瓶用量酌减,盖HAO瓶盖后在倒置显微镜下观察。当细胞收回突起变圆时立即翻转培养瓶,使细胞脱离胰酶,然后将胰酶倒掉。注意勿使细胞提早脱落入消化中;⑨加入少量的含血清的新鲜培养基,反复吹打消化HAO的细胞使其脱壁并分散,再根据分传瓶数补加一定量的含血清的新鲜培养基(7-10ml/大瓶;3-5ml/小瓶)制成细胞悬,然后分装到新培养瓶中。盖HAO瓶盖,适度拧紧后稍回转,以利于CO2的进入,将培养瓶放回CO2培养箱;⑩对悬浮培养细胞,步骤7-9不做。直接将细胞悬进行离心去除旧培养基上清,加入新鲜培养基,然后分装到各瓶中。
IPLB-Sf21 Cells;背景说明:详见相关文献介绍;传代方法:1:2-1:3传代;每周换液2-3次。;生长特性:贴壁或悬浮,详见产品说明部分;形态特性:详见产品说明;相关产品有:OV-2008 Cells、HNTEC Cells、KYSE-510 Cells
ARO81-1 Cells;背景说明:甲状腺癌;女性;传代方法:1:2-1:3传代;每周换液2-3次。;生长特性:贴壁;形态特性:详见产品说明;相关产品有:IBRS2 Cells、Bowes melanoma cells Cells、CoCL2 Cells
NCI-H1703 Cells;背景说明:该细胞1987年建系,源自一位54岁患有非小细胞肺癌的白人男性,该患者为吸烟者。;传代方法:1:3—1:6传代,每周换液2—3次;生长特性:贴壁生长;形态特性:上皮细胞样;相关产品有:LC1sq Cells、NH-6 Cells、OVCAR3 Cells
FL 62891 Cells;背景说明:肝;SV40转化;男性;传代方法:1:2-1:3传代;每周换液2-3次。;生长特性:贴壁;形态特性:详见产品说明;相关产品有:HL60 Cells、NCI-SNU-216 Cells、KPL-1 Cells
MV 3 Cells;背景说明:黑色素瘤;淋巴结转移;男性;传代方法:1:2-1:3传代;每周换液2-3次。;生长特性:贴壁;形态特性:详见产品说明;相关产品有:MDAMB361 Cells、UCLA SO M21 Cells、Stanford University Pediatric T-cell line 1 Cells
K562/ADR Cells;背景说明:详见相关文献介绍;传代方法:1:2-1:3传代;每周换液2-3次。;生长特性:贴壁或悬浮,详见产品说明部分;形态特性:详见产品说明;相关产品有:LCMS Cells、PG-4 Cells、HSC-I Cells
SK-NSH Cells;背景说明:SK-N-SH细胞系由J.L.Bieder建系,它与SK-N-MC所不同的是倍增时间较长且多巴胺-β-羟基酶水平较高。 SK-N-SH在细胞介导的细胞毒性试验中用作靶细胞系。;传代方法:1:2传代;生长特性:悬浮生长;形态特性:上皮细胞样;相关产品有:COV-362 Cells、HCC 38 Cells、C4-1 Cells
SKRC-52 Cells;背景说明:肾癌;纵隔膜转移;传代方法:1:2-1:3传代;每周换液2-3次。;生长特性:贴壁;形态特性:详见产品说明;相关产品有:VA-ES-BJ Cells、Ly19 Cells、Sci-1 Cells
MLTC-1 Cells;背景说明:睾丸间质瘤;传代方法:1:2-1:3传代;每周换液2-3次。;生长特性:贴壁;形态特性:详见产品说明;相关产品有:MV3 Cells、HemECs Cells、SK N SH Cells
HCa/16A3-F Cells;背景说明:肝癌;传代方法:1:2-1:3传代;每周换液2-3次。;生长特性:贴壁;形态特性:详见产品说明;相关产品有:SHEP1 Cells、CCK-81 Cells、RA.1 Cells
SF-539 BT Cells;背景说明:胶质瘤;女性;传代方法:1:2-1:3传代;每周换液2-3次。;生长特性:贴壁;形态特性:详见产品说明;相关产品有:SCL1 Cells、Liver-02 Cells、RMC Cells
GM0637 Cells;背景说明:详见相关文献介绍;传代方法:1:2-1:3传代;每周换液2-3次。;生长特性:贴壁或悬浮,详见产品说明部分;形态特性:详见产品说明;相关产品有:SUM149 Cells、TOV112D Cells、Leukemic 1210 Cells
RKO Cells;背景说明:RKO是一个低分化的结肠癌细胞系。RKO细胞含有野生型P53,但缺乏人甲状腺受体核受体(h-TRbeta1)。RKO细胞的P53蛋白的水平高于RKO-E6细胞。RKO细胞系是RKO-E6和RKO-AS45-1的亲本细胞系。该细胞系在裸鼠中成瘤,且在软琼脂中形成集落。;传代方法:消化3-5分钟。1:2。3天内可长满。;生长特性:贴壁生长;形态特性:上皮样;相关产品有:WM451Lu Cells、SKML-28 Cells、HSC(Human Schwann) Cells
SW-1573 Cells;背景说明:详见相关文献介绍;传代方法:1:2-1:3传代;每周换液2-3次。;生长特性:贴壁或悬浮,详见产品说明部分;形态特性:详见产品说明;相关产品有:MDBK (NBL-1) Cells、IM 9 Cells、NR 8383 Cells
NFS-60 Cells;背景说明:详见相关文献介绍;传代方法:1:3传代;生长特性:贴壁生长;形态特性:上皮细胞样;相关产品有:Hs-600-T Cells、MeSoTheliOma-211H Cells、293 H Cells
H9/HTLV-IIIB人T淋巴瘤白血病细胞系
HEMCSS Cells;背景说明:详见相关文献介绍;传代方法:1:4-1:8传代;每周换液3次。;生长特性:贴壁生长;形态特性:详见产品说明;相关产品有:STTG1 Cells、SKCO 1 Cells、RL95 Cells
LADMAC Cells;背景说明:骨髓淋巴细胞;C3H;传代方法:1:2-1:3传代;每周换液2-3次。;生长特性:悬浮;形态特性:详见产品说明;相关产品有:TO175T Cells、MRC 5 Cells、FHCRC subclone 11 Cells
Abcam HCT 116 FEN1 KO Cells(拥有STR基因鉴定图谱)
AG06292 Cells(拥有STR基因鉴定图谱)
BayGenomics ES cell line CSI617 Cells(拥有STR基因鉴定图谱)
BayGenomics ES cell line RST749 Cells(拥有STR基因鉴定图谱)
BIHi269-A Cells(拥有STR基因鉴定图谱)
CIBi005-A Cells(拥有STR基因鉴定图谱)
┈订┈购┈热┈线:1┈5┈8┈0┈0┈5┈7┈6┈8┈6┈7【微信同号】┈Q┈Q:3┈3┈0┈7┈2┈0┈4┈2┈7┈1;
DA03222 Cells(拥有STR基因鉴定图谱)
DT40-ORAI2(-/-) Cells(拥有STR基因鉴定图谱)
GM03983 Cells(拥有STR基因鉴定图谱)
SU-DHL-10 Cells;背景说明:详见相关文献介绍;传代方法:1:2-1:3传代;每周换液2-3次。;生长特性:悬浮;形态特性:淋巴母细胞;相关产品有:BC-020 Cells、Rat-2 Cells、NCIH2170 Cells
H2228 Cells;背景说明:详见相关文献介绍;传代方法:1:2-1:3传代,每周2-3次。;生长特性:贴壁生长;形态特性:详见产品说明;相关产品有:Ocular Choroidal Melanoma-1 Cells、N87 Cells、210RCY3-Ag1.2.3 Cells
KG-1 Cells;背景说明:详见相关文献介绍;传代方法:1:3传代,2-3天传一代;生长特性:悬浮生长;形态特性:原粒细胞;相关产品有:SPC-A1 Cells、Hs 895.T Cells、AMJ2-C8 Cells
G422 Cells;背景说明:1964年建株;甲基胆蒽植入Km小鼠脑内诱发星形细胞瘤,传至第120代后转为胶质细胞瘤;瘤细胞悬液同系小鼠皮下、肌肉、脑内移植,成功率皆100%。肌肉及脑内移植可形成较规律的移植性瘤株,存活时间脑内型15.9±4.8天;肌肉型20.3±6.6天。;传代方法:1:2传代;生长特性:体内生长;形态特性:实体瘤;相关产品有:SKGT2 Cells、B16F1 Cells、H-2170 Cells
Leghorn Male Hepatoma cell line Cells;背景说明:肝癌;雄性;传代方法:1:2-1:3传代;每周换液2-3次。;生长特性:贴壁;形态特性:详见产品说明;相关产品有:2V6.11 Cells、P-19 Cells、COR-L 105 Cells
MNNG/HOS Clone F-5 Cells;背景说明:骨肉瘤;女性;传代方法:1:2-1:3传代;每周换液2-3次。;生长特性:贴壁;形态特性:详见产品说明;相关产品有:SJSA1 Cells、DHL-16 Cells、GM02131A Cells
RT-BM Cells;背景说明:详见相关文献介绍;传代方法:1:2传代;生长特性:贴壁生长;形态特性:成神经细胞;相关产品有:DHL6 Cells、H-740 Cells、OKAC1 Cells
MNNG-HOS (Cl#5) Cells;背景说明:骨肉瘤;女性;传代方法:1:2-1:3传代;每周换液2-3次。;生长特性:贴壁;形态特性:详见产品说明;相关产品有:P31-FUJ Cells、HCGC Cells、Hi-5 Cells
MC-38 Cells;背景说明:详见相关文献介绍;传代方法:1:2传代;生长特性:贴壁生长;形态特性:上皮细胞样;相关产品有:OE-21 Cells、SUDHL8 Cells、HeLa S3 Cells
RL95-2 Cells;背景说明:这些细胞有α角蛋白,定义明确的连接复合体,张力丝和表面微绒毛。;传代方法:1:2传代;生长特性:贴壁生长;形态特性:上皮样;相关产品有:Clone 166 Cells、GM03570 Cells、Molm 13 Cells
4T1.2 Cells;背景说明:乳腺癌;雌性;BALB/cfC3H;传代方法:1:2-1:3传代;每周换液2-3次。;生长特性:贴壁;形态特性:详见产品说明;相关产品有:SHG-44 Cells、143 B Cells、Colon26 Cells
Tu 212 Cells;背景说明:详见相关文献介绍;传代方法:1:2传代;生长特性:贴壁生长 ;形态特性:详见产品说明;相关产品有:H-187 Cells、769P Cells、ssMCF7 Cells
NCTC-929 Cells;背景说明:详见相关文献介绍;传代方法:1:2-1:3传代;每周换液2-3次。;生长特性:贴壁或悬浮,详见产品说明部分;形态特性:详见产品说明;相关产品有:SW1417 Cells、HGSMC Cells、HO8910PM Cells
7-1 [Mouse hybridoma against ouabain] Cells(拥有STR基因鉴定图谱)
P31FUJ Cells;背景说明:详见相关文献介绍;传代方法:1:5传代;生长特性:悬浮生长;形态特性:淋巴母细胞;相关产品有:DHL-16 Cells、ME1 Cells、FU-OV-1 Cells
EOC20 Cells;背景说明:详见相关文献介绍;传代方法:1:2-1:3传代;每周换液2-3次。;生长特性:贴壁或悬浮,详见产品说明部分;形态特性:详见产品说明;相关产品有:COV-434 Cells、AgC11x3A Cells、Madin-Darby Canine Kidney Cells
CP-70 Cells;背景说明:卵巢癌;女性;传代方法:1:2-1:3传代;每周换液2-3次。;生长特性:贴壁;形态特性:详见产品说明;相关产品有:MHCC97-H Cells、SNU-5 Cells、UMC-11 Cells
G 292 Clone A 141B1 Cells;背景说明:详见相关文献介绍;传代方法:1:2-1:3传代;每周换液2-3次。;生长特性:贴壁或悬浮,详见产品说明部分;形态特性:详见产品说明;相关产品有:T-HEECs Cells、COV504 Cells、X63-AG 8.653 Cells
BERH-2 Cells;背景说明:肝癌;传代方法:1:2-1:3传代;每周换液2-3次。;生长特性:贴壁;形态特性:详见产品说明;相关产品有:MM1-S Cells、HL-7702 Cells、Roswell Park Memorial Institute 2650 Cells
THP1 Cells;背景说明:该细胞从一名1岁的患有急性单核细胞性白血病的男孩的外周血中分离建立。该细胞可以吞噬乳胶颗粒和激活的红细胞,细胞膜和胞浆内均没有免疫球蛋白,表达C3R和FcR;可受佛波酯TPA诱导向单核系方向分化;可作为转染宿主。;传代方法:维持细胞浓度在2-4×105-8×105/ml,勿超过1×106/ml;2-3天换液1次。;生长特性:悬浮生长;形态特性:单核细胞;相关产品有:HBVP Cells、WM115-mel Cells、MUTZ3 Cells
NCI.H522 Cells;背景说明:详见相关文献介绍;传代方法:1:3-1:6传代;每周换液2-3次。;生长特性:贴壁生长;形态特性:上皮样;相关产品有:PG-4 (S+L-) Cells、GM03573A Cells、NS1-1 Ag4.1 Cells
Tu-686 Cells;背景说明:详见相关文献介绍;传代方法:1:2传代;生长特性:贴壁生长 ;形态特性:详见产品说明;相关产品有:HEK-AD 293 Cells、Tohoku Hospital Pediatrics-1 Cells、ROS 17/2.8 Cells
GM10542 Cells(拥有STR基因鉴定图谱)
HAP1 CD2BP2 (-) 1 Cells(拥有STR基因鉴定图谱)
MALME 3M Cells;背景说明:详见相关文献介绍;传代方法:1:2-1:4传代,2天换液1次。;生长特性:混合生长;形态特性:成纤维细胞;相关产品有:A204 Cells、HaCaT Cells、MDCK II Cells
HG03857 Cells(拥有STR基因鉴定图谱)
IL-A24 Cells(拥有STR基因鉴定图谱)
LSV5 Cells(拥有STR基因鉴定图谱)
ND01091 Cells(拥有STR基因鉴定图谱)
PC6-12 Cells(拥有STR基因鉴定图谱)
Ubigene HeLa ATP13A2 KO Cells(拥有STR基因鉴定图谱)
WT-CLS1 Cells(拥有STR基因鉴定图谱)
HAP1 SOAT1 (-) 1 Cells(拥有STR基因鉴定图谱)
AU 565 Cells;背景说明:详见相关文献介绍;传代方法:1:4—1:6传代;每3-5天换一次液。;生长特性:贴壁生长;形态特性:上皮细胞;相关产品有:Det 562 Cells、OCM1 Cells、WC00097 Cells
MDA-415 Cells;背景说明:这株细胞表达WNT7B癌基因。8168088].带瘤患者来自巴拉圭,虽然填报的是白人,但细胞表型存在G6PDA型,显示其属于混血。细胞株形成平展延伸的上皮细胞样,在电镜下呈现结节,伴随着延伸的微管和微板。不容易用胰酶消化。;传代方法:消化5-10分钟。1:2。4-5天长满。;生长特性:贴壁生长;形态特性:上皮细胞;相关产品有:HUVEC Cells、Mouse INsulinoma 6 Cells、C22 (Clara) Cells
FAO-1 Cells;背景说明:详见相关文献介绍;传代方法:1:2-1:3传代;每周换液2-3次。;生长特性:贴壁或悬浮,详见产品说明部分;形态特性:上皮细胞;相关产品有:LS 174 T Cells、CORL23 Cells、NCI-H2330 Cells
MRCV Cells;背景说明:MRC-5细胞系来自14周龄男性胎儿的正常肺组织,该细胞老化前能传代42~46个倍增时间。;传代方法:1:2-1:5传代;每周1-2次。;生长特性:贴壁生长;形态特性:成纤维细胞样;相关产品有:NCI-H524 Cells、BEP2D Cells、D-283 Cells
FM-88 Cells;背景说明:详见相关文献介绍;传代方法:1:2-1:3传代;每周换液2-3次。;生长特性:贴壁或悬浮,详见产品说明部分;形态特性:详见产品说明;相关产品有:KM H-2 Cells、MC26 Cells、N1E115 Cells
FM-88 Cells;背景说明:详见相关文献介绍;传代方法:1:2-1:3传代;每周换液2-3次。;生长特性:贴壁或悬浮,详见产品说明部分;形态特性:详见产品说明;相关产品有:KM H-2 Cells、MC26 Cells、N1E115 Cells
ASPC1 Cells;背景说明:该细胞来源于人胰腺癌裸鼠异种移植产生的癌性腹水,可以表达CEA,人胰腺相关抗原、人胰腺特异性抗原和黏蛋白。;传代方法:1:3-1:6传代;每周换液2-3次。;生长特性:贴壁生长;形态特性:上皮样;相关产品有:HT-144 Cells、TE671/RD Cells、MFM223 Cells
LS180 Cells;背景说明:详见相关文献介绍;传代方法:1:2-1:3传代;每周换液2-3次。;生长特性:贴壁或悬浮,详见产品说明部分;形态特性:详见产品说明;相关产品有:SW982 Cells、MDA-MB453 Cells、Hs 294T Cells
MCF12A Cells;背景说明:非致瘤性乳腺上皮细胞;女性;传代方法:1:2-1:3传代;每周换液2-3次。;生长特性:贴壁;形态特性:详见产品说明;相关产品有:EST50 Cells、NCI-SNU-C2B Cells、GC-2 Cells
HS578 Cells;背景说明:详见相关文献介绍;传代方法:1:2-1:3传代;每周换液2-3次。;生长特性:贴壁或悬浮,详见产品说明部分;形态特性:详见产品说明;相关产品有:CAMA-1 Cells、SCCVII/St Cells、MT-3 [Human leukocytes] Cells
FL62891 Cells;背景说明:肝;SV40转化;男性;传代方法:1:2-1:3传代;每周换液2-3次。;生长特性:贴壁;形态特性:详见产品说明;相关产品有:PCI-SG231 Cells、SNU-601 Cells、SNU-668 Cells
FOX-NY Cells;背景说明:详见相关文献介绍;传代方法:1:2-1:3传代;每周换液2-3次。;生长特性:贴壁或悬浮,详见产品说明部分;形态特性:详见产品说明;相关产品有:A-875 Cells、C8161 Cells、MLO-Y4 Cells
Lewis lung carcinoma line 1 Cells;背景说明:详见相关文献介绍;传代方法:1:2-1:3传代;每周换液2-3次。;生长特性:贴壁或悬浮,详见产品说明部分;形态特性:详见产品说明;相关产品有:MDA157 Cells、IPEC-1 Cells、SNU119 Cells
MV4:11 Cells;背景说明:详见相关文献介绍;传代方法:1:2-1:3传代;每周换液2-3次。;生长特性:贴壁或悬浮,详见产品说明部分;形态特性:详见产品说明;相关产品有:P30OHK Cells、K1 Cells、BXPC3 Cells
NKL Cells;背景说明:NK细胞淋巴瘤/白血病;男性;传代方法:1:2-1:3传代;每周换液2-3次。;生长特性:悬浮;形态特性:详见产品说明;相关产品有:Kobe university Oral Squamous Cell culture-2 Cells、C4-2 B Cells、SW 1222 Cells
SCRP0307i Cells(拥有STR基因鉴定图谱)
COLO-699 Cells;背景说明:详见相关文献介绍;传代方法:1:2-1:3传代;每周换液2-3次。;生长特性:贴壁或悬浮,详见产品说明部分;形态特性:详见产品说明;相关产品有:LI7 Cells、CMT-64 Cells、BSC-1 Cells
U-373MG ATCC Cells;背景说明:胶质瘤;男性;传代方法:1:2-1:3传代;每周换液2-3次。;生长特性:贴壁;形态特性:详见产品说明;相关产品有:IPLB-Sf21-AE Cells、A2780-CP Cells、HK-2 [Human kidney] Cells
ST 486 Cells;背景说明:详见相关文献介绍;传代方法:每2-3天换液;生长特性:悬浮生长 ;形态特性:淋巴母细胞样;相关产品有:HCEC-B4G12 Cells、KLN 205 Cells、BMF Cells
MDA-MB-231-GFP Cells;背景说明:详见相关文献介绍;传代方法:1:2-1:3传代;每周换液2-3次。;生长特性:贴壁或悬浮,详见产品说明部分;形态特性:详见产品说明;相关产品有:EJ Cells、LuCL4 Cells、BTI-Tn-5B1-4 Cells
Jurkat FHCRC Cells;背景说明:该细胞源自一位14岁患有T淋巴细胞白血病男性的外周血;传代方法:保持细胞密度在3—9×105cells/ml之间,1:5—1:10传代,每周换液2—3次;生长特性:悬浮生长;形态特性:圆形,单个或呈片;相关产品有:SCC-1395 Cells、KMY1022 Cells、SNK6 Cells
GM05887A Cells;背景说明:详见相关文献介绍;传代方法:1:2—1:5传代;每周换液2-3次;生长特性:贴壁生长;形态特性:混合型;相关产品有:MDCK Type II Cells、H2196 Cells、CORL51 Cells
┈订┈购┈热┈线:1┈5┈8┈0┈0┈5┈7┈6┈8┈6┈7【微信同号】┈Q┈Q:3┈3┈0┈7┈2┈0┈4┈2┈7┈1;
ST2 Cells;背景说明:基质;BALB/c;传代方法:1:2-1:3传代;每周换液2-3次。;生长特性:贴壁;形态特性:详见产品说明;相关产品有:R D Cells、RS4:11 Cells、Hs675 Cells
H711 Cells;背景说明:详见相关文献介绍;传代方法:1:2-1:3传代;每周换液2-3次。;生长特性:贴壁或悬浮,详见产品说明部分;形态特性:详见产品说明;相关产品有:IMCD-3 Cells、SW 982 Cells、MGHU3 Cells
TSU-Pr1 Cells;背景说明:详见相关文献介绍;传代方法:1:2传代;生长特性:贴壁生长;形态特性:上皮细胞样;相关产品有:H1568 Cells、COLO-829 Cells、R.K.13 Cells
CII Cells;背景说明:慢性淋巴细胞白血病;女性;传代方法:1:2-1:3传代;每周换液2-3次。;生长特性:悬浮;形态特性:详见产品说明;相关产品有:MLFC Cells、H-735 Cells、LS411 Cells
A2780S Cells;背景说明:详见相关文献介绍;传代方法:1:2传代;生长特性:贴壁生长;形态特性:上皮细胞样;相关产品有:OE-33 Cells、FCCH1018 Cells、MAC1 Cells
RL Cells;背景说明:详见相关文献介绍;传代方法:每周换液2-3次。;生长特性:悬浮生长 ;形态特性:淋巴母细胞样;相关产品有:SCC90 Cells、HIBEpiC Cells、SW 1573 Cells
M059J Cells;背景说明:详见相关文献介绍;传代方法:1:6-1:8传代;每周换液2-3次。;生长特性:贴壁生长;形态特性:成纤维细胞;相关产品有:MGECs Cells、SKBR-3 Cells、MDCC MSB1 Cells
H9/HTLV-IIIB人T淋巴瘤白血病细胞系
SU-DHL-16 Cells;背景说明:详见相关文献介绍;传代方法:1:2-1:3传代;每周换液2-3次。;生长特性:贴壁或悬浮,详见产品说明部分;形态特性:详见产品说明;相关产品有:RPMI8226 Cells、C4 I Cells、OUMS27 Cells
BayGenomics ES cell line RRN132 Cells(拥有STR基因鉴定图谱)
BayGenomics ES cell line YHA186 Cells(拥有STR基因鉴定图谱)
H20E03 Cells(拥有STR基因鉴定图谱)
P4bis Cells(拥有STR基因鉴定图谱)
ACK30 Cells(拥有STR基因鉴定图谱)
HOC519 Cells(拥有STR基因鉴定图谱)
" "PubMed=19727395; DOI=10.1371/journal.pone.0006888; PMCID=PMC2731225
Wadlow R.C., Wittner B.S., Finley S.A., Bergquist H., Upadhyay R., Finn S.P., Loda M., Mahmood U., Ramaswamy S.
Systems-level modeling of cancer-fibroblast interaction.
PLoS ONE 4:E6888-E6888(2009)
PubMed=20164919; DOI=10.1038/nature08768; PMCID=PMC3145113
Bignell G.R., Greenman C.D., Davies H.R., Butler A.P., Edkins S., Andrews J.M., Buck G., Chen L., Beare D., Latimer C., Widaa S., Hinton J., Fahey C., Fu B.-Y., Swamy S., Dalgliesh G.L., Teh B.T., Deloukas P., Yang F.-T., Campbell P.J., Futreal P.A., Stratton M.R.
Signatures of mutation and selection in the cancer genome.
Nature 463:893-898(2010)
PubMed=20215515; DOI=10.1158/0008-5472.CAN-09-3458; PMCID=PMC2881662
Rothenberg S.M., Mohapatra G., Rivera M.N., Winokur D., Greninger P., Nitta M., Sadow P.M., Sooriyakumar G., Brannigan B.W., Ulman M.J., Perera R.M., Wang R., Tam A., Ma X.-J., Erlander M., Sgroi D.C., Rocco J.W., Lingen M.W., Cohen E.E.W., Louis D.N., Settleman J., Haber D.A.
A genome-wide screen for microdeletions reveals disruption of polarity complex genes in diverse human cancers.
Cancer Res. 70:2158-2164(2010)
PubMed=20557307; DOI=10.1111/j.1349-7006.2010.01622.x; PMCID=PMC11158680
Iwakawa R., Kohno T., Enari M., Kiyono T., Yokota J.
Prevalence of human papillomavirus 16/18/33 infection and p53 mutation in lung adenocarcinoma.
Cancer Sci. 101:1891-1896(2010)
PubMed=21498706
Onitsuka T., Uramoto H., Tanaka F.
Lack of direct association between EGFR mutations and ER beta expression in lung cancer.
Anticancer Res. 31:855-860(2011)
PubMed=22460905; DOI=10.1038/nature11003; PMCID=PMC3320027
Barretina J.G., Caponigro G., Stransky N., Venkatesan K., Margolin A.A., Kim S., Wilson C.J., Lehar J., Kryukov G.V., Sonkin D., Reddy A., Liu M., Murray L., Berger M.F., Monahan J.E., Morais P., Meltzer J., Korejwa A., Jane-Valbuena J., Mapa F.A., Thibault J., Bric-Furlong E., Raman P., Shipway A., Engels I.H., Cheng J., Yu G.-Y.K., Yu J.-J., Aspesi P. Jr., de Silva M., Jagtap K., Jones M.D., Wang L., Hatton C., Palescandolo E., Gupta S., Mahan S., Sougnez C., Onofrio R.C., Liefeld T., MacConaill L.E., Winckler W., Reich M., Li N.-X., Mesirov J.P., Gabriel S.B., Getz G., Ardlie K., Chan V., Myer V.E., Weber B.L., Porter J., Warmuth M., Finan P., Harris J.L., Meyerson M.L., Golub T.R., Morrissey M.P., Sellers W.R., Schlegel R., Garraway L.A.
The Cancer Cell Line Encyclopedia enables predictive modelling of anticancer drug sensitivity.
Nature 483:603-607(2012)
PubMed=22961666; DOI=10.1158/2159-8290.CD-12-0112; PMCID=PMC3567922
Byers L.A., Wang J., Nilsson M.B., Fujimoto J., Saintigny P., Yordy J.S., Giri U., Peyton M., Fan Y.-H., Diao L.-X., Masrorpour F., Shen L., Liu W.-B., Duchemann B., Tumula P., Bhardwaj V., Welsh J., Weber S., Glisson B.S., Kalhor N., Wistuba I.I., Girard L., Lippman S.M., Mills G.B., Coombes K.R., Weinstein J.N., Minna J.D., Heymach J.V.
Proteomic profiling identifies dysregulated pathways in small cell lung cancer and novel therapeutic targets including PARP1.
Cancer Discov. 2:798-811(2012)
PubMed=25008024; DOI=10.1007/s10735-014-9583-2
Wang J., Wei H., Zhao B.-X., Li M., Lv W.-P., Lv L., Song B., Lv S.
The reverse effect of X-ray irradiation on acquired gefitinib resistance in non-small cell lung cancer cell line NCI-H1975 in vitro.
J. Mol. Histol. 45:641-652(2014)
PubMed=25984343; DOI=10.1038/sdata.2014.35; PMCID=PMC4432652
Cowley G.S., Weir B.A., Vazquez F., Tamayo P., Scott J.A., Rusin S., East-Seletsky A., Ali L.D., Gerath W.F.J., Pantel S.E., Lizotte P.H., Jiang G.-Z., Hsiao J., Tsherniak A., Dwinell E., Aoyama S., Okamoto M., Harrington W., Gelfand E.T., Green T.M., Tomko M.J., Gopal S., Wong T.C., Li H.-B., Howell S., Stransky N., Liefeld T., Jang D., Bistline J., Meyers B.H., Armstrong S.A., Anderson K.C., Stegmaier K., Reich M., Pellman D., Boehm J.S., Mesirov J.P., Golub T.R., Root D.E., Hahn W.C.
Parallel genome-scale loss of function screens in 216 cancer cell lines for the identification of context-specific genetic dependencies.
Sci. Data 1:140035-140035(2014)
PubMed=25483995; DOI=10.3892/mmr.2014.3058
Zhao B.-X., Wang J., Song B., Wei H., Lv W.-P., Tian L.-M., Li M., Lv S.
Establishment and biological characteristics of acquired gefitinib resistance in cell line NCI-H1975/gefinitib-resistant with epidermal growth factor receptor T790M mutation.
Mol. Med. Rep. 11:2767-2774(2015)
PubMed=25485619; DOI=10.1038/nbt.3080
Klijn C., Durinck S., Stawiski E.W., Haverty P.M., Jiang Z.-S., Liu H.-B., Degenhardt J., Mayba O., Gnad F., Liu J.-F., Pau G., Reeder J., Cao Y., Mukhyala K., Selvaraj S.K., Yu M.-M., Zynda G.J., Brauer M.J., Wu T.D., Gentleman R.C., Manning G., Yauch R.L., Bourgon R., Stokoe D., Modrusan Z., Neve R.M., de Sauvage F.J., Settleman J., Seshagiri S., Zhang Z.-M.
A comprehensive transcriptional portrait of human cancer cell lines.
Nat. Biotechnol. 33:306-312(2015)
PubMed=25877200; DOI=10.1038/nature14397
Yu M., Selvaraj S.K., Liang-Chu M.M.Y., Aghajani S., Busse M., Yuan J., Lee G., Peale F.V., Klijn C., Bourgon R., Kaminker J.S., Neve R.M.
A resource for cell line authentication, annotation and quality control.
Nature 520:307-311(2015)
PubMed=26202522; DOI=10.1021/acs.jproteome.5b00477; PMCID=PMC4761227
Kitata R.B., Dimayacyac-Esleta B.R.T., Choong W.-K., Tsai C.-F., Lin T.-D., Tsou C.-C., Weng S.-H., Chen Y.-J., Yang P.-C., Arco S.D., Nesvizhskii A.I., Sung T.-Y., Chen Y.-J.
Mining missing membrane proteins by high-pH reverse-phase stagetip fractionation and multiple reaction monitoring mass spectrometry.
J. Proteome Res. 14:3658-3669(2015)
PubMed=26554430; DOI=10.1021/acs.analchem.5b03639
Dimayacyac-Esleta B.R.T., Tsai C.-F., Kitata R.B., Lin P.-Y., Choong W.-K., Lin T.-D., Wang Y.-T., Weng S.-H., Yang P.-C., Arco S.D., Sung T.-Y., Chen Y.-J.
Rapid high-pH reverse phase stagetip for sensitive small-scale membrane proteomic profiling.
Anal. Chem. 87:12016-12023(2015)
PubMed=26589293; DOI=10.1186/s13073-015-0240-5; PMCID=PMC4653878
Scholtalbers J., Boegel S., Bukur T., Byl M., Goerges S., Sorn P., Loewer M., Sahin U., Castle J.C.
TCLP: an online cancer cell line catalogue integrating HLA type, predicted neo-epitopes, virus and gene expression.
Genome Med. 7:118.1-118.7(2015)
PubMed=27397505; DOI=10.1016/j.cell.2016.06.017; PMCID=PMC4967469
Iorio F., Knijnenburg T.A., Vis D.J., Bignell G.R., Menden M.P., Schubert M., Aben N., Goncalves E., Barthorpe S., Lightfoot H., Cokelaer T., Greninger P., van Dyk E., Chang H., de Silva H., Heyn H., Deng X.-M., Egan R.K., Liu Q.-S., Miroo T., Mitropoulos X., Richardson L., Wang J.-H., Zhang T.-H., Moran S., Sayols S., Soleimani M., Tamborero D., Lopez-Bigas N., Ross-Macdonald P., Esteller M., Gray N.S., Haber D.A., Stratton M.R., Benes C.H., Wessels L.F.A., Saez-Rodriguez J., McDermott U., Garnett M.J.
A landscape of pharmacogenomic interactions in cancer.
Cell 166:740-754(2016)
PubMed=27835594; DOI=10.18632/oncotarget.13150; PMCID=PMC5348415
Tang Z.-H., Jiang X.-M., Guo X., Fong C.M.V., Chen X.-P., Lu J.-J.
Characterization of osimertinib (AZD9291)-resistant non-small cell lung cancer NCI-H1975/OSIR cell line.
Oncotarget 7:81598-81610(2016)
PubMed=28196595; DOI=10.1016/j.ccell.2017.01.005; PMCID=PMC5501076
Li J., Zhao W., Akbani R., Liu W.-B., Ju Z.-L., Ling S.-Y., Vellano C.P., Roebuck P., Yu Q.-H., Eterovic A.K., Byers L.A., Davies M.A., Deng W.-L., Gopal Y.N.V., Chen G., von Euw E.M., Slamon D.J., Conklin D., Heymach J.V., Gazdar A.F., Minna J.D., Myers J.N., Lu Y.-L., Mills G.B., Liang H.
Characterization of human cancer cell lines by reverse-phase protein arrays.
Cancer Cell 31:225-239(2017)
PubMed=29444439; DOI=10.1016/j.celrep.2018.01.051; PMCID=PMC6343826
Yuan T.L., Amzallag A., Bagni R., Yi M., Afghani S., Burgan W., Fer N., Strathern L.A., Powell K., Smith B., Waters A.M., Drubin D.A., Thomson T., Liao R., Greninger P., Stein G.T., Murchie E., Cortez E., Egan R.K., Procter L., Bess M., Cheng K.T., Lee C.-S., Lee L.C., Fellmann C., Stephens R., Luo J., Lowe S.W., Benes C.H., McCormick F.
Differential effector engagement by oncogenic KRAS.
Cell Rep. 22:1889-1902(2018)
PubMed=29681454; DOI=10.1016/j.cell.2018.03.028; PMCID=PMC5935540
McMillan E.A., Ryu M.-J., Diep C.H., Mendiratta S., Clemenceau J.R., Vaden R.M., Kim J.-H., Motoyaji T., Covington K.R., Peyton M., Huffman K., Wu X.-F., Girard L., Sung Y., Chen P.-H., Mallipeddi P.L., Lee J.Y., Hanson J., Voruganti S., Yu Y., Park S., Sudderth J., DeSevo C., Muzny D.M., Doddapaneni H., Gazdar A.F., Gibbs R.A., Hwang T.H., Heymach J.V., Wistuba I.I., Coombes K.R., Williams N.S., Wheeler D.A., MacMillan J.B., DeBerardinis R.J., Roth M.G., Posner B.A., Minna J.D., Kim H.S., White M.A.
Chemistry-first approach for nomination of personalized treatment in lung cancer.
Cell 173:864-878.e29(2018)
PubMed=30710758; DOI=10.1016/j.jprot.2019.01.018
Bottger F., Schaaij-Visser T.B.M., de Reus I., Piersma S.R., Pham T.V., Nagel R., Brakenhoff R.H., Thunnissen E., Smit E.F., Jimenez C.R.
Proteome analysis of non-small cell lung cancer cell line secretomes and patient sputum reveals biofluid biomarker candidates for cisplatin response prediction.
J. Proteomics 196:106-119(2019)
PubMed=30894373; DOI=10.1158/0008-5472.CAN-18-2747; PMCID=PMC6445675
Dutil J., Chen Z.-H., Monteiro A.N.A., Teer J.K., Eschrich S.A.
An interactive resource to probe genetic diversity and estimated ancestry in cancer cell lines.
Cancer Res. 79:1263-1273(2019)
PubMed=30971826; DOI=10.1038/s41586-019-1103-9
Behan F.M., Iorio F., Picco G., Goncalves E., Beaver C.M., Migliardi G., Santos R., Rao Y., Sassi F., Pinnelli M., Ansari R., Harper S., Jackson D.A., McRae R., Pooley R., Wilkinson P., van der Meer D.J., Dow D., Buser-Doepner C.A., Bertotti A., Trusolino L., Stronach E.A., Saez-Rodriguez J., Yusa K., Garnett M.J.
Prioritization of cancer therapeutic targets using CRISPR-Cas9 screens.
Nature 568:511-516(2019)
PubMed=31068700; DOI=10.1038/s41586-019-1186-3; PMCID=PMC6697103
Ghandi M., Huang F.W., Jane-Valbuena J., Kryukov G.V., Lo C.C., McDonald E.R. 3rd, Barretina J.G., Gelfand E.T., Bielski C.M., Li H.-X., Hu K., Andreev-Drakhlin A.Y., Kim J., Hess J.M., Haas B.J., Aguet F., Weir B.A., Rothberg M.V., Paolella B.R., Lawrence M.S., Akbani R., Lu Y.-L., Tiv H.L., Gokhale P.C., de Weck A., Mansour A.A., Oh C., Shih J., Hadi K., Rosen Y., Bistline J., Venkatesan K., Reddy A., Sonkin D., Liu M., Lehar J., Korn J.M., Porter D.A., Jones M.D., Golji J., Caponigro G., Taylor J.E., Dunning C.M., Creech A.L., Warren A.C., McFarland J.M., Zamanighomi M., Kauffmann A., Stransky N., Imielinski M., Maruvka Y.E., Cherniack A.D., Tsherniak A., Vazquez F., Jaffe J.D., Lane A.A., Weinstock D.M., Johannessen C.M., Morrissey M.P., Stegmeier F., Schlegel R., Hahn W.C., Getz G., Mills G.B., Boehm J.S., Golub T.R., Garraway L.A., Sellers W.R.
Next-generation characterization of the Cancer Cell Line Encyclopedia.
Nature 569:503-508(2019)
PubMed=31803961; DOI=10.1002/jcb.29564; PMCID=PMC7496084
Mulshine J.L., Ujhazy P., Antman M., Burgess C.M., Kuzmin I.A., Bunn P.A. Jr., Johnson B.E., Roth J.A., Pass H.I., Ross S.M., Aldige C.R., Wistuba I.I., Minna J.D.
From clinical specimens to human cancer preclinical models -- a journey the NCI-cell line database-25 years later.
J. Cell. Biochem. 121:3986-3999(2020)
PubMed=31978347; DOI=10.1016/j.cell.2019.12.023; PMCID=PMC7339254
Nusinow D.P., Szpyt J., Ghandi M., Rose C.M., McDonald E.R. 3rd, Kalocsay M., Jane-Valbuena J., Gelfand E.T., Schweppe D.K., Jedrychowski M.P., Golji J., Porter D.A., Rejtar T., Wang Y.K., Kryukov G.V., Stegmeier F., Erickson B.K., Garraway L.A., Sellers W.R., Gygi S.P.
Quantitative proteomics of the Cancer Cell Line Encyclopedia.
Cell 180:387-402.e16(2020)
PubMed=32351780; DOI=10.7717/peerj.8779; PMCID=PMC7183755
Wu J.-Y., Hao Z.-F., Ma C., Li P.-F., Dang L.-Y., Sun S.-S.
Comparative proteogenomics profiling of non-small and small lung carcinoma cell lines using mass spectrometry.
PeerJ 8:e8779.1-e8779.19(2020)"
风险提示:丁香通仅作为第三方平台,为商家信息发布提供平台空间。用户咨询产品时请注意保护个人信息及财产安全,合理判断,谨慎选购商品,商家和用户对交易行为负责。对于医疗器械类产品,请先查证核实企业经营资质和医疗器械产品注册证情况。
文献和实验该产品被引用文献
"PubMed=19727395; DOI=10.1371/journal.pone.0006888; PMCID=PMC2731225
Wadlow R.C., Wittner B.S., Finley S.A., Bergquist H., Upadhyay R., Finn S.P., Loda M., Mahmood U., Ramaswamy S.
Systems-level modeling of cancer-fibroblast interaction.
PLoS ONE 4:E6888-E6888(2009)
PubMed=20164919; DOI=10.1038/nature08768; PMCID=PMC3145113
Bignell G.R., Greenman C.D., Davies H.R., Butler A.P., Edkins S., Andrews J.M., Buck G., Chen L., Beare D., Latimer C., Widaa S., Hinton J., Fahey C., Fu B.-Y., Swamy S., Dalgliesh G.L., Teh B.T., Deloukas P., Yang F.-T., Campbell P.J., Futreal P.A., Stratton M.R.
Signatures of mutation and selection in the cancer genome.
Nature 463:893-898(2010)
PubMed=20215515; DOI=10.1158/0008-5472.CAN-09-3458; PMCID=PMC2881662
Rothenberg S.M., Mohapatra G., Rivera M.N., Winokur D., Greninger P., Nitta M., Sadow P.M., Sooriyakumar G., Brannigan B.W., Ulman M.J., Perera R.M., Wang R., Tam A., Ma X.-J., Erlander M., Sgroi D.C., Rocco J.W., Lingen M.W., Cohen E.E.W., Louis D.N., Settleman J., Haber D.A.
A genome-wide screen for microdeletions reveals disruption of polarity complex genes in diverse human cancers.
Cancer Res. 70:2158-2164(2010)
PubMed=20557307; DOI=10.1111/j.1349-7006.2010.01622.x; PMCID=PMC11158680
Iwakawa R., Kohno T., Enari M., Kiyono T., Yokota J.
Prevalence of human papillomavirus 16/18/33 infection and p53 mutation in lung adenocarcinoma.
Cancer Sci. 101:1891-1896(2010)
PubMed=21498706
Onitsuka T., Uramoto H., Tanaka F.
Lack of direct association between EGFR mutations and ER beta expression in lung cancer.
Anticancer Res. 31:855-860(2011)
PubMed=22460905; DOI=10.1038/nature11003; PMCID=PMC3320027
Barretina J.G., Caponigro G., Stransky N., Venkatesan K., Margolin A.A., Kim S., Wilson C.J., Lehar J., Kryukov G.V., Sonkin D., Reddy A., Liu M., Murray L., Berger M.F., Monahan J.E., Morais P., Meltzer J., Korejwa A., Jane-Valbuena J., Mapa F.A., Thibault J., Bric-Furlong E., Raman P., Shipway A., Engels I.H., Cheng J., Yu G.-Y.K., Yu J.-J., Aspesi P. Jr., de Silva M., Jagtap K., Jones M.D., Wang L., Hatton C., Palescandolo E., Gupta S., Mahan S., Sougnez C., Onofrio R.C., Liefeld T., MacConaill L.E., Winckler W., Reich M., Li N.-X., Mesirov J.P., Gabriel S.B., Getz G., Ardlie K., Chan V., Myer V.E., Weber B.L., Porter J., Warmuth M., Finan P., Harris J.L., Meyerson M.L., Golub T.R., Morrissey M.P., Sellers W.R., Schlegel R., Garraway L.A.
The Cancer Cell Line Encyclopedia enables predictive modelling of anticancer drug sensitivity.
Nature 483:603-607(2012)
PubMed=22961666; DOI=10.1158/2159-8290.CD-12-0112; PMCID=PMC3567922
Byers L.A., Wang J., Nilsson M.B., Fujimoto J., Saintigny P., Yordy J.S., Giri U., Peyton M., Fan Y.-H., Diao L.-X., Masrorpour F., Shen L., Liu W.-B., Duchemann B., Tumula P., Bhardwaj V., Welsh J., Weber S., Glisson B.S., Kalhor N., Wistuba I.I., Girard L., Lippman S.M., Mills G.B., Coombes K.R., Weinstein J.N., Minna J.D., Heymach J.V.
Proteomic profiling identifies dysregulated pathways in small cell lung cancer and novel therapeutic targets including PARP1.
Cancer Discov. 2:798-811(2012)
PubMed=25008024; DOI=10.1007/s10735-014-9583-2
Wang J., Wei H., Zhao B.-X., Li M., Lv W.-P., Lv L., Song B., Lv S.
The reverse effect of X-ray irradiation on acquired gefitinib resistance in non-small cell lung cancer cell line NCI-H1975 in vitro.
J. Mol. Histol. 45:641-652(2014)
PubMed=25984343; DOI=10.1038/sdata.2014.35; PMCID=PMC4432652
Cowley G.S., Weir B.A., Vazquez F., Tamayo P., Scott J.A., Rusin S., East-Seletsky A., Ali L.D., Gerath W.F.J., Pantel S.E., Lizotte P.H., Jiang G.-Z., Hsiao J., Tsherniak A., Dwinell E., Aoyama S., Okamoto M., Harrington W., Gelfand E.T., Green T.M., Tomko M.J., Gopal S., Wong T.C., Li H.-B., Howell S., Stransky N., Liefeld T., Jang D., Bistline J., Meyers B.H., Armstrong S.A., Anderson K.C., Stegmaier K., Reich M., Pellman D., Boehm J.S., Mesirov J.P., Golub T.R., Root D.E., Hahn W.C.
Parallel genome-scale loss of function screens in 216 cancer cell lines for the identification of context-specific genetic dependencies.
Sci. Data 1:140035-140035(2014)
PubMed=25483995; DOI=10.3892/mmr.2014.3058
Zhao B.-X., Wang J., Song B., Wei H., Lv W.-P., Tian L.-M., Li M., Lv S.
Establishment and biological characteristics of acquired gefitinib resistance in cell line NCI-H1975/gefinitib-resistant with epidermal growth factor receptor T790M mutation.
Mol. Med. Rep. 11:2767-2774(2015)
PubMed=25485619; DOI=10.1038/nbt.3080
Klijn C., Durinck S., Stawiski E.W., Haverty P.M., Jiang Z.-S., Liu H.-B., Degenhardt J., Mayba O., Gnad F., Liu J.-F., Pau G., Reeder J., Cao Y., Mukhyala K., Selvaraj S.K., Yu M.-M., Zynda G.J., Brauer M.J., Wu T.D., Gentleman R.C., Manning G., Yauch R.L., Bourgon R., Stokoe D., Modrusan Z., Neve R.M., de Sauvage F.J., Settleman J., Seshagiri S., Zhang Z.-M.
A comprehensive transcriptional portrait of human cancer cell lines.
Nat. Biotechnol. 33:306-312(2015)
PubMed=25877200; DOI=10.1038/nature14397
Yu M., Selvaraj S.K., Liang-Chu M.M.Y., Aghajani S., Busse M., Yuan J., Lee G., Peale F.V., Klijn C., Bourgon R., Kaminker J.S., Neve R.M.
A resource for cell line authentication, annotation and quality control.
Nature 520:307-311(2015)
PubMed=26202522; DOI=10.1021/acs.jproteome.5b00477; PMCID=PMC4761227
Kitata R.B., Dimayacyac-Esleta B.R.T., Choong W.-K., Tsai C.-F., Lin T.-D., Tsou C.-C., Weng S.-H., Chen Y.-J., Yang P.-C., Arco S.D., Nesvizhskii A.I., Sung T.-Y., Chen Y.-J.
Mining missing membrane proteins by high-pH reverse-phase stagetip fractionation and multiple reaction monitoring mass spectrometry.
J. Proteome Res. 14:3658-3669(2015)
PubMed=26554430; DOI=10.1021/acs.analchem.5b03639
Dimayacyac-Esleta B.R.T., Tsai C.-F., Kitata R.B., Lin P.-Y., Choong W.-K., Lin T.-D., Wang Y.-T., Weng S.-H., Yang P.-C., Arco S.D., Sung T.-Y., Chen Y.-J.
Rapid high-pH reverse phase stagetip for sensitive small-scale membrane proteomic profiling.
Anal. Chem. 87:12016-12023(2015)
PubMed=26589293; DOI=10.1186/s13073-015-0240-5; PMCID=PMC4653878
Scholtalbers J., Boegel S., Bukur T., Byl M., Goerges S., Sorn P., Loewer M., Sahin U., Castle J.C.
TCLP: an online cancer cell line catalogue integrating HLA type, predicted neo-epitopes, virus and gene expression.
Genome Med. 7:118.1-118.7(2015)
PubMed=27397505; DOI=10.1016/j.cell.2016.06.017; PMCID=PMC4967469
Iorio F., Knijnenburg T.A., Vis D.J., Bignell G.R., Menden M.P., Schubert M., Aben N., Goncalves E., Barthorpe S., Lightfoot H., Cokelaer T., Greninger P., van Dyk E., Chang H., de Silva H., Heyn H., Deng X.-M., Egan R.K., Liu Q.-S., Miroo T., Mitropoulos X., Richardson L., Wang J.-H., Zhang T.-H., Moran S., Sayols S., Soleimani M., Tamborero D., Lopez-Bigas N., Ross-Macdonald P., Esteller M., Gray N.S., Haber D.A., Stratton M.R., Benes C.H., Wessels L.F.A., Saez-Rodriguez J., McDermott U., Garnett M.J.
A landscape of pharmacogenomic interactions in cancer.
Cell 166:740-754(2016)
PubMed=27835594; DOI=10.18632/oncotarget.13150; PMCID=PMC5348415
Tang Z.-H., Jiang X.-M., Guo X., Fong C.M.V., Chen X.-P., Lu J.-J.
Characterization of osimertinib (AZD9291)-resistant non-small cell lung cancer NCI-H1975/OSIR cell line.
Oncotarget 7:81598-81610(2016)
PubMed=28196595; DOI=10.1016/j.ccell.2017.01.005; PMCID=PMC5501076
Li J., Zhao W., Akbani R., Liu W.-B., Ju Z.-L., Ling S.-Y., Vellano C.P., Roebuck P., Yu Q.-H., Eterovic A.K., Byers L.A., Davies M.A., Deng W.-L., Gopal Y.N.V., Chen G., von Euw E.M., Slamon D.J., Conklin D., Heymach J.V., Gazdar A.F., Minna J.D., Myers J.N., Lu Y.-L., Mills G.B., Liang H.
Characterization of human cancer cell lines by reverse-phase protein arrays.
Cancer Cell 31:225-239(2017)
PubMed=29444439; DOI=10.1016/j.celrep.2018.01.051; PMCID=PMC6343826
Yuan T.L., Amzallag A., Bagni R., Yi M., Afghani S., Burgan W., Fer N., Strathern L.A., Powell K., Smith B., Waters A.M., Drubin D.A., Thomson T., Liao R., Greninger P., Stein G.T., Murchie E., Cortez E., Egan R.K., Procter L., Bess M., Cheng K.T., Lee C.-S., Lee L.C., Fellmann C., Stephens R., Luo J., Lowe S.W., Benes C.H., McCormick F.
Differential effector engagement by oncogenic KRAS.
Cell Rep. 22:1889-1902(2018)
PubMed=29681454; DOI=10.1016/j.cell.2018.03.028; PMCID=PMC5935540
McMillan E.A., Ryu M.-J., Diep C.H., Mendiratta S., Clemenceau J.R., Vaden R.M., Kim J.-H., Motoyaji T., Covington K.R., Peyton M., Huffman K., Wu X.-F., Girard L., Sung Y., Chen P.-H., Mallipeddi P.L., Lee J.Y., Hanson J., Voruganti S., Yu Y., Park S., Sudderth J., DeSevo C., Muzny D.M., Doddapaneni H., Gazdar A.F., Gibbs R.A., Hwang T.H., Heymach J.V., Wistuba I.I., Coombes K.R., Williams N.S., Wheeler D.A., MacMillan J.B., DeBerardinis R.J., Roth M.G., Posner B.A., Minna J.D., Kim H.S., White M.A.
Chemistry-first approach for nomination of personalized treatment in lung cancer.
Cell 173:864-878.e29(2018)
PubMed=30710758; DOI=10.1016/j.jprot.2019.01.018
Bottger F., Schaaij-Visser T.B.M., de Reus I., Piersma S.R., Pham T.V., Nagel R., Brakenhoff R.H., Thunnissen E., Smit E.F., Jimenez C.R.
Proteome analysis of non-small cell lung cancer cell line secretomes and patient sputum reveals biofluid biomarker candidates for cisplatin response prediction.
J. Proteomics 196:106-119(2019)
PubMed=30894373; DOI=10.1158/0008-5472.CAN-18-2747; PMCID=PMC6445675
Dutil J., Chen Z.-H., Monteiro A.N.A., Teer J.K., Eschrich S.A.
An interactive resource to probe genetic diversity and estimated ancestry in cancer cell lines.
Cancer Res. 79:1263-1273(2019)
PubMed=30971826; DOI=10.1038/s41586-019-1103-9
Behan F.M., Iorio F., Picco G., Goncalves E., Beaver C.M., Migliardi G., Santos R., Rao Y., Sassi F., Pinnelli M., Ansari R., Harper S., Jackson D.A., McRae R., Pooley R., Wilkinson P., van der Meer D.J., Dow D., Buser-Doepner C.A., Bertotti A., Trusolino L., Stronach E.A., Saez-Rodriguez J., Yusa K., Garnett M.J.
Prioritization of cancer therapeutic targets using CRISPR-Cas9 screens.
Nature 568:511-516(2019)
PubMed=31068700; DOI=10.1038/s41586-019-1186-3; PMCID=PMC6697103
Ghandi M., Huang F.W., Jane-Valbuena J., Kryukov G.V., Lo C.C., McDonald E.R. 3rd, Barretina J.G., Gelfand E.T., Bielski C.M., Li H.-X., Hu K., Andreev-Drakhlin A.Y., Kim J., Hess J.M., Haas B.J., Aguet F., Weir B.A., Rothberg M.V., Paolella B.R., Lawrence M.S., Akbani R., Lu Y.-L., Tiv H.L., Gokhale P.C., de Weck A., Mansour A.A., Oh C., Shih J., Hadi K., Rosen Y., Bistline J., Venkatesan K., Reddy A., Sonkin D., Liu M., Lehar J., Korn J.M., Porter D.A., Jones M.D., Golji J., Caponigro G., Taylor J.E., Dunning C.M., Creech A.L., Warren A.C., McFarland J.M., Zamanighomi M., Kauffmann A., Stransky N., Imielinski M., Maruvka Y.E., Cherniack A.D., Tsherniak A., Vazquez F., Jaffe J.D., Lane A.A., Weinstock D.M., Johannessen C.M., Morrissey M.P., Stegmeier F., Schlegel R., Hahn W.C., Getz G., Mills G.B., Boehm J.S., Golub T.R., Garraway L.A., Sellers W.R.
Next-generation characterization of the Cancer Cell Line Encyclopedia.
Nature 569:503-508(2019)
PubMed=31803961; DOI=10.1002/jcb.29564; PMCID=PMC7496084
Mulshine J.L., Ujhazy P., Antman M., Burgess C.M., Kuzmin I.A., Bunn P.A. Jr., Johnson B.E., Roth J.A., Pass H.I., Ross S.M., Aldige C.R., Wistuba I.I., Minna J.D.
From clinical specimens to human cancer preclinical models -- a journey the NCI-cell line database-25 years later.
J. Cell. Biochem. 121:3986-3999(2020)
PubMed=31978347; DOI=10.1016/j.cell.2019.12.023; PMCID=PMC7339254
Nusinow D.P., Szpyt J., Ghandi M., Rose C.M., McDonald E.R. 3rd, Kalocsay M., Jane-Valbuena J., Gelfand E.T., Schweppe D.K., Jedrychowski M.P., Golji J., Porter D.A., Rejtar T., Wang Y.K., Kryukov G.V., Stegmeier F., Erickson B.K., Garraway L.A., Sellers W.R., Gygi S.P.
Quantitative proteomics of the Cancer Cell Line Encyclopedia.
Cell 180:387-402.e16(2020)
PubMed=32351780; DOI=10.7717/peerj.8779; PMCID=PMC7183755
Wu J.-Y., Hao Z.-F., Ma C., Li P.-F., Dang L.-Y., Sun S.-S.
Comparative proteogenomics profiling of non-small and small lung carcinoma cell lines using mass spectrometry.
PeerJ 8:e8779.1-e8779.19(2020)"
Wadlow R.C., Wittner B.S., Finley S.A., Bergquist H., Upadhyay R., Finn S.P., Loda M., Mahmood U., Ramaswamy S.
Systems-level modeling of cancer-fibroblast interaction.
PLoS ONE 4:E6888-E6888(2009)
PubMed=20164919; DOI=10.1038/nature08768; PMCID=PMC3145113
Bignell G.R., Greenman C.D., Davies H.R., Butler A.P., Edkins S., Andrews J.M., Buck G., Chen L., Beare D., Latimer C., Widaa S., Hinton J., Fahey C., Fu B.-Y., Swamy S., Dalgliesh G.L., Teh B.T., Deloukas P., Yang F.-T., Campbell P.J., Futreal P.A., Stratton M.R.
Signatures of mutation and selection in the cancer genome.
Nature 463:893-898(2010)
PubMed=20215515; DOI=10.1158/0008-5472.CAN-09-3458; PMCID=PMC2881662
Rothenberg S.M., Mohapatra G., Rivera M.N., Winokur D., Greninger P., Nitta M., Sadow P.M., Sooriyakumar G., Brannigan B.W., Ulman M.J., Perera R.M., Wang R., Tam A., Ma X.-J., Erlander M., Sgroi D.C., Rocco J.W., Lingen M.W., Cohen E.E.W., Louis D.N., Settleman J., Haber D.A.
A genome-wide screen for microdeletions reveals disruption of polarity complex genes in diverse human cancers.
Cancer Res. 70:2158-2164(2010)
PubMed=20557307; DOI=10.1111/j.1349-7006.2010.01622.x; PMCID=PMC11158680
Iwakawa R., Kohno T., Enari M., Kiyono T., Yokota J.
Prevalence of human papillomavirus 16/18/33 infection and p53 mutation in lung adenocarcinoma.
Cancer Sci. 101:1891-1896(2010)
PubMed=21498706
Onitsuka T., Uramoto H., Tanaka F.
Lack of direct association between EGFR mutations and ER beta expression in lung cancer.
Anticancer Res. 31:855-860(2011)
PubMed=22460905; DOI=10.1038/nature11003; PMCID=PMC3320027
Barretina J.G., Caponigro G., Stransky N., Venkatesan K., Margolin A.A., Kim S., Wilson C.J., Lehar J., Kryukov G.V., Sonkin D., Reddy A., Liu M., Murray L., Berger M.F., Monahan J.E., Morais P., Meltzer J., Korejwa A., Jane-Valbuena J., Mapa F.A., Thibault J., Bric-Furlong E., Raman P., Shipway A., Engels I.H., Cheng J., Yu G.-Y.K., Yu J.-J., Aspesi P. Jr., de Silva M., Jagtap K., Jones M.D., Wang L., Hatton C., Palescandolo E., Gupta S., Mahan S., Sougnez C., Onofrio R.C., Liefeld T., MacConaill L.E., Winckler W., Reich M., Li N.-X., Mesirov J.P., Gabriel S.B., Getz G., Ardlie K., Chan V., Myer V.E., Weber B.L., Porter J., Warmuth M., Finan P., Harris J.L., Meyerson M.L., Golub T.R., Morrissey M.P., Sellers W.R., Schlegel R., Garraway L.A.
The Cancer Cell Line Encyclopedia enables predictive modelling of anticancer drug sensitivity.
Nature 483:603-607(2012)
PubMed=22961666; DOI=10.1158/2159-8290.CD-12-0112; PMCID=PMC3567922
Byers L.A., Wang J., Nilsson M.B., Fujimoto J., Saintigny P., Yordy J.S., Giri U., Peyton M., Fan Y.-H., Diao L.-X., Masrorpour F., Shen L., Liu W.-B., Duchemann B., Tumula P., Bhardwaj V., Welsh J., Weber S., Glisson B.S., Kalhor N., Wistuba I.I., Girard L., Lippman S.M., Mills G.B., Coombes K.R., Weinstein J.N., Minna J.D., Heymach J.V.
Proteomic profiling identifies dysregulated pathways in small cell lung cancer and novel therapeutic targets including PARP1.
Cancer Discov. 2:798-811(2012)
PubMed=25008024; DOI=10.1007/s10735-014-9583-2
Wang J., Wei H., Zhao B.-X., Li M., Lv W.-P., Lv L., Song B., Lv S.
The reverse effect of X-ray irradiation on acquired gefitinib resistance in non-small cell lung cancer cell line NCI-H1975 in vitro.
J. Mol. Histol. 45:641-652(2014)
PubMed=25984343; DOI=10.1038/sdata.2014.35; PMCID=PMC4432652
Cowley G.S., Weir B.A., Vazquez F., Tamayo P., Scott J.A., Rusin S., East-Seletsky A., Ali L.D., Gerath W.F.J., Pantel S.E., Lizotte P.H., Jiang G.-Z., Hsiao J., Tsherniak A., Dwinell E., Aoyama S., Okamoto M., Harrington W., Gelfand E.T., Green T.M., Tomko M.J., Gopal S., Wong T.C., Li H.-B., Howell S., Stransky N., Liefeld T., Jang D., Bistline J., Meyers B.H., Armstrong S.A., Anderson K.C., Stegmaier K., Reich M., Pellman D., Boehm J.S., Mesirov J.P., Golub T.R., Root D.E., Hahn W.C.
Parallel genome-scale loss of function screens in 216 cancer cell lines for the identification of context-specific genetic dependencies.
Sci. Data 1:140035-140035(2014)
PubMed=25483995; DOI=10.3892/mmr.2014.3058
Zhao B.-X., Wang J., Song B., Wei H., Lv W.-P., Tian L.-M., Li M., Lv S.
Establishment and biological characteristics of acquired gefitinib resistance in cell line NCI-H1975/gefinitib-resistant with epidermal growth factor receptor T790M mutation.
Mol. Med. Rep. 11:2767-2774(2015)
PubMed=25485619; DOI=10.1038/nbt.3080
Klijn C., Durinck S., Stawiski E.W., Haverty P.M., Jiang Z.-S., Liu H.-B., Degenhardt J., Mayba O., Gnad F., Liu J.-F., Pau G., Reeder J., Cao Y., Mukhyala K., Selvaraj S.K., Yu M.-M., Zynda G.J., Brauer M.J., Wu T.D., Gentleman R.C., Manning G., Yauch R.L., Bourgon R., Stokoe D., Modrusan Z., Neve R.M., de Sauvage F.J., Settleman J., Seshagiri S., Zhang Z.-M.
A comprehensive transcriptional portrait of human cancer cell lines.
Nat. Biotechnol. 33:306-312(2015)
PubMed=25877200; DOI=10.1038/nature14397
Yu M., Selvaraj S.K., Liang-Chu M.M.Y., Aghajani S., Busse M., Yuan J., Lee G., Peale F.V., Klijn C., Bourgon R., Kaminker J.S., Neve R.M.
A resource for cell line authentication, annotation and quality control.
Nature 520:307-311(2015)
PubMed=26202522; DOI=10.1021/acs.jproteome.5b00477; PMCID=PMC4761227
Kitata R.B., Dimayacyac-Esleta B.R.T., Choong W.-K., Tsai C.-F., Lin T.-D., Tsou C.-C., Weng S.-H., Chen Y.-J., Yang P.-C., Arco S.D., Nesvizhskii A.I., Sung T.-Y., Chen Y.-J.
Mining missing membrane proteins by high-pH reverse-phase stagetip fractionation and multiple reaction monitoring mass spectrometry.
J. Proteome Res. 14:3658-3669(2015)
PubMed=26554430; DOI=10.1021/acs.analchem.5b03639
Dimayacyac-Esleta B.R.T., Tsai C.-F., Kitata R.B., Lin P.-Y., Choong W.-K., Lin T.-D., Wang Y.-T., Weng S.-H., Yang P.-C., Arco S.D., Sung T.-Y., Chen Y.-J.
Rapid high-pH reverse phase stagetip for sensitive small-scale membrane proteomic profiling.
Anal. Chem. 87:12016-12023(2015)
PubMed=26589293; DOI=10.1186/s13073-015-0240-5; PMCID=PMC4653878
Scholtalbers J., Boegel S., Bukur T., Byl M., Goerges S., Sorn P., Loewer M., Sahin U., Castle J.C.
TCLP: an online cancer cell line catalogue integrating HLA type, predicted neo-epitopes, virus and gene expression.
Genome Med. 7:118.1-118.7(2015)
PubMed=27397505; DOI=10.1016/j.cell.2016.06.017; PMCID=PMC4967469
Iorio F., Knijnenburg T.A., Vis D.J., Bignell G.R., Menden M.P., Schubert M., Aben N., Goncalves E., Barthorpe S., Lightfoot H., Cokelaer T., Greninger P., van Dyk E., Chang H., de Silva H., Heyn H., Deng X.-M., Egan R.K., Liu Q.-S., Miroo T., Mitropoulos X., Richardson L., Wang J.-H., Zhang T.-H., Moran S., Sayols S., Soleimani M., Tamborero D., Lopez-Bigas N., Ross-Macdonald P., Esteller M., Gray N.S., Haber D.A., Stratton M.R., Benes C.H., Wessels L.F.A., Saez-Rodriguez J., McDermott U., Garnett M.J.
A landscape of pharmacogenomic interactions in cancer.
Cell 166:740-754(2016)
PubMed=27835594; DOI=10.18632/oncotarget.13150; PMCID=PMC5348415
Tang Z.-H., Jiang X.-M., Guo X., Fong C.M.V., Chen X.-P., Lu J.-J.
Characterization of osimertinib (AZD9291)-resistant non-small cell lung cancer NCI-H1975/OSIR cell line.
Oncotarget 7:81598-81610(2016)
PubMed=28196595; DOI=10.1016/j.ccell.2017.01.005; PMCID=PMC5501076
Li J., Zhao W., Akbani R., Liu W.-B., Ju Z.-L., Ling S.-Y., Vellano C.P., Roebuck P., Yu Q.-H., Eterovic A.K., Byers L.A., Davies M.A., Deng W.-L., Gopal Y.N.V., Chen G., von Euw E.M., Slamon D.J., Conklin D., Heymach J.V., Gazdar A.F., Minna J.D., Myers J.N., Lu Y.-L., Mills G.B., Liang H.
Characterization of human cancer cell lines by reverse-phase protein arrays.
Cancer Cell 31:225-239(2017)
PubMed=29444439; DOI=10.1016/j.celrep.2018.01.051; PMCID=PMC6343826
Yuan T.L., Amzallag A., Bagni R., Yi M., Afghani S., Burgan W., Fer N., Strathern L.A., Powell K., Smith B., Waters A.M., Drubin D.A., Thomson T., Liao R., Greninger P., Stein G.T., Murchie E., Cortez E., Egan R.K., Procter L., Bess M., Cheng K.T., Lee C.-S., Lee L.C., Fellmann C., Stephens R., Luo J., Lowe S.W., Benes C.H., McCormick F.
Differential effector engagement by oncogenic KRAS.
Cell Rep. 22:1889-1902(2018)
PubMed=29681454; DOI=10.1016/j.cell.2018.03.028; PMCID=PMC5935540
McMillan E.A., Ryu M.-J., Diep C.H., Mendiratta S., Clemenceau J.R., Vaden R.M., Kim J.-H., Motoyaji T., Covington K.R., Peyton M., Huffman K., Wu X.-F., Girard L., Sung Y., Chen P.-H., Mallipeddi P.L., Lee J.Y., Hanson J., Voruganti S., Yu Y., Park S., Sudderth J., DeSevo C., Muzny D.M., Doddapaneni H., Gazdar A.F., Gibbs R.A., Hwang T.H., Heymach J.V., Wistuba I.I., Coombes K.R., Williams N.S., Wheeler D.A., MacMillan J.B., DeBerardinis R.J., Roth M.G., Posner B.A., Minna J.D., Kim H.S., White M.A.
Chemistry-first approach for nomination of personalized treatment in lung cancer.
Cell 173:864-878.e29(2018)
PubMed=30710758; DOI=10.1016/j.jprot.2019.01.018
Bottger F., Schaaij-Visser T.B.M., de Reus I., Piersma S.R., Pham T.V., Nagel R., Brakenhoff R.H., Thunnissen E., Smit E.F., Jimenez C.R.
Proteome analysis of non-small cell lung cancer cell line secretomes and patient sputum reveals biofluid biomarker candidates for cisplatin response prediction.
J. Proteomics 196:106-119(2019)
PubMed=30894373; DOI=10.1158/0008-5472.CAN-18-2747; PMCID=PMC6445675
Dutil J., Chen Z.-H., Monteiro A.N.A., Teer J.K., Eschrich S.A.
An interactive resource to probe genetic diversity and estimated ancestry in cancer cell lines.
Cancer Res. 79:1263-1273(2019)
PubMed=30971826; DOI=10.1038/s41586-019-1103-9
Behan F.M., Iorio F., Picco G., Goncalves E., Beaver C.M., Migliardi G., Santos R., Rao Y., Sassi F., Pinnelli M., Ansari R., Harper S., Jackson D.A., McRae R., Pooley R., Wilkinson P., van der Meer D.J., Dow D., Buser-Doepner C.A., Bertotti A., Trusolino L., Stronach E.A., Saez-Rodriguez J., Yusa K., Garnett M.J.
Prioritization of cancer therapeutic targets using CRISPR-Cas9 screens.
Nature 568:511-516(2019)
PubMed=31068700; DOI=10.1038/s41586-019-1186-3; PMCID=PMC6697103
Ghandi M., Huang F.W., Jane-Valbuena J., Kryukov G.V., Lo C.C., McDonald E.R. 3rd, Barretina J.G., Gelfand E.T., Bielski C.M., Li H.-X., Hu K., Andreev-Drakhlin A.Y., Kim J., Hess J.M., Haas B.J., Aguet F., Weir B.A., Rothberg M.V., Paolella B.R., Lawrence M.S., Akbani R., Lu Y.-L., Tiv H.L., Gokhale P.C., de Weck A., Mansour A.A., Oh C., Shih J., Hadi K., Rosen Y., Bistline J., Venkatesan K., Reddy A., Sonkin D., Liu M., Lehar J., Korn J.M., Porter D.A., Jones M.D., Golji J., Caponigro G., Taylor J.E., Dunning C.M., Creech A.L., Warren A.C., McFarland J.M., Zamanighomi M., Kauffmann A., Stransky N., Imielinski M., Maruvka Y.E., Cherniack A.D., Tsherniak A., Vazquez F., Jaffe J.D., Lane A.A., Weinstock D.M., Johannessen C.M., Morrissey M.P., Stegmeier F., Schlegel R., Hahn W.C., Getz G., Mills G.B., Boehm J.S., Golub T.R., Garraway L.A., Sellers W.R.
Next-generation characterization of the Cancer Cell Line Encyclopedia.
Nature 569:503-508(2019)
PubMed=31803961; DOI=10.1002/jcb.29564; PMCID=PMC7496084
Mulshine J.L., Ujhazy P., Antman M., Burgess C.M., Kuzmin I.A., Bunn P.A. Jr., Johnson B.E., Roth J.A., Pass H.I., Ross S.M., Aldige C.R., Wistuba I.I., Minna J.D.
From clinical specimens to human cancer preclinical models -- a journey the NCI-cell line database-25 years later.
J. Cell. Biochem. 121:3986-3999(2020)
PubMed=31978347; DOI=10.1016/j.cell.2019.12.023; PMCID=PMC7339254
Nusinow D.P., Szpyt J., Ghandi M., Rose C.M., McDonald E.R. 3rd, Kalocsay M., Jane-Valbuena J., Gelfand E.T., Schweppe D.K., Jedrychowski M.P., Golji J., Porter D.A., Rejtar T., Wang Y.K., Kryukov G.V., Stegmeier F., Erickson B.K., Garraway L.A., Sellers W.R., Gygi S.P.
Quantitative proteomics of the Cancer Cell Line Encyclopedia.
Cell 180:387-402.e16(2020)
PubMed=32351780; DOI=10.7717/peerj.8779; PMCID=PMC7183755
Wu J.-Y., Hao Z.-F., Ma C., Li P.-F., Dang L.-Y., Sun S.-S.
Comparative proteogenomics profiling of non-small and small lung carcinoma cell lines using mass spectrometry.
PeerJ 8:e8779.1-e8779.19(2020)"
文献支持
H9/HTLV-IIIB人T淋巴瘤白血病细胞系
¥850 - 5500